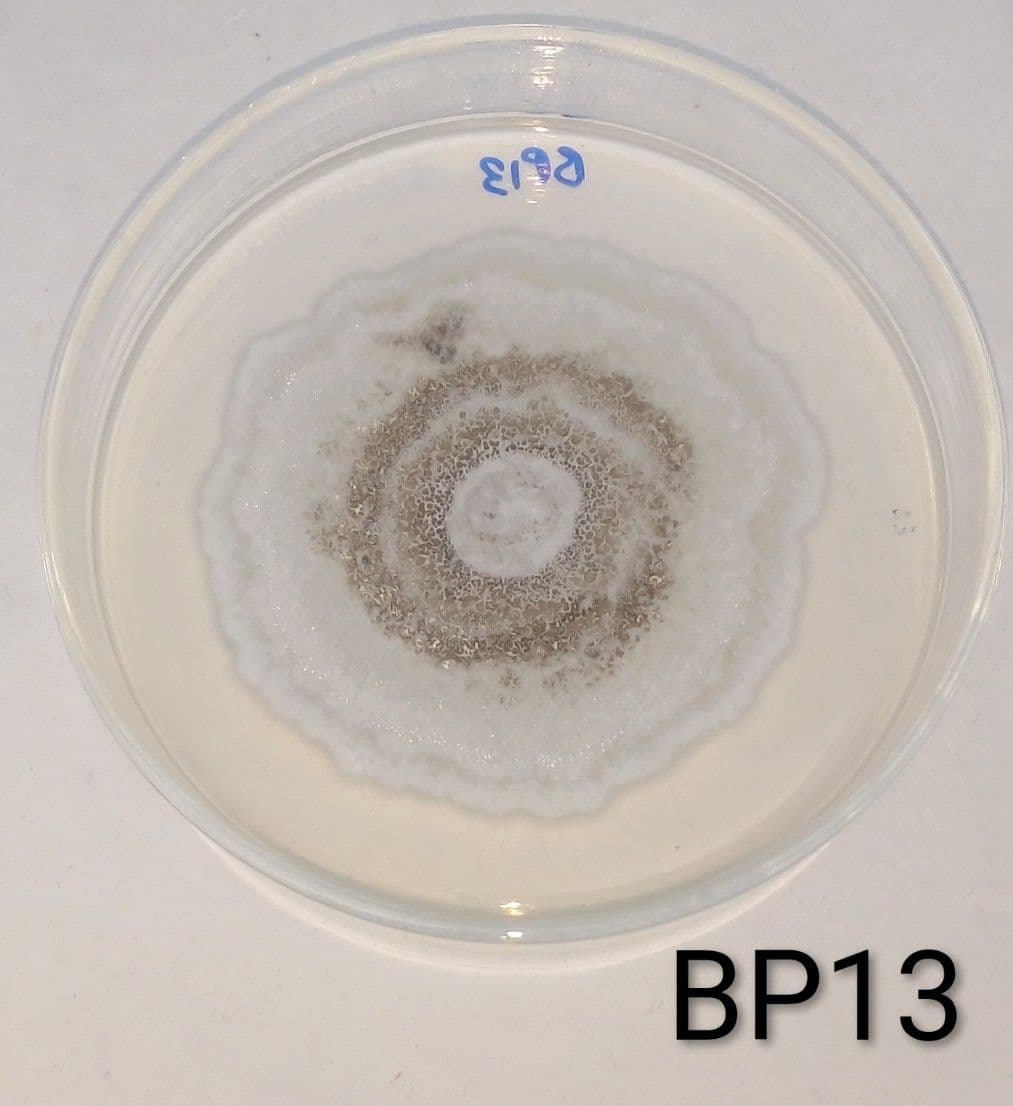
Circular fungal colony on a Petri dish labeled BP13
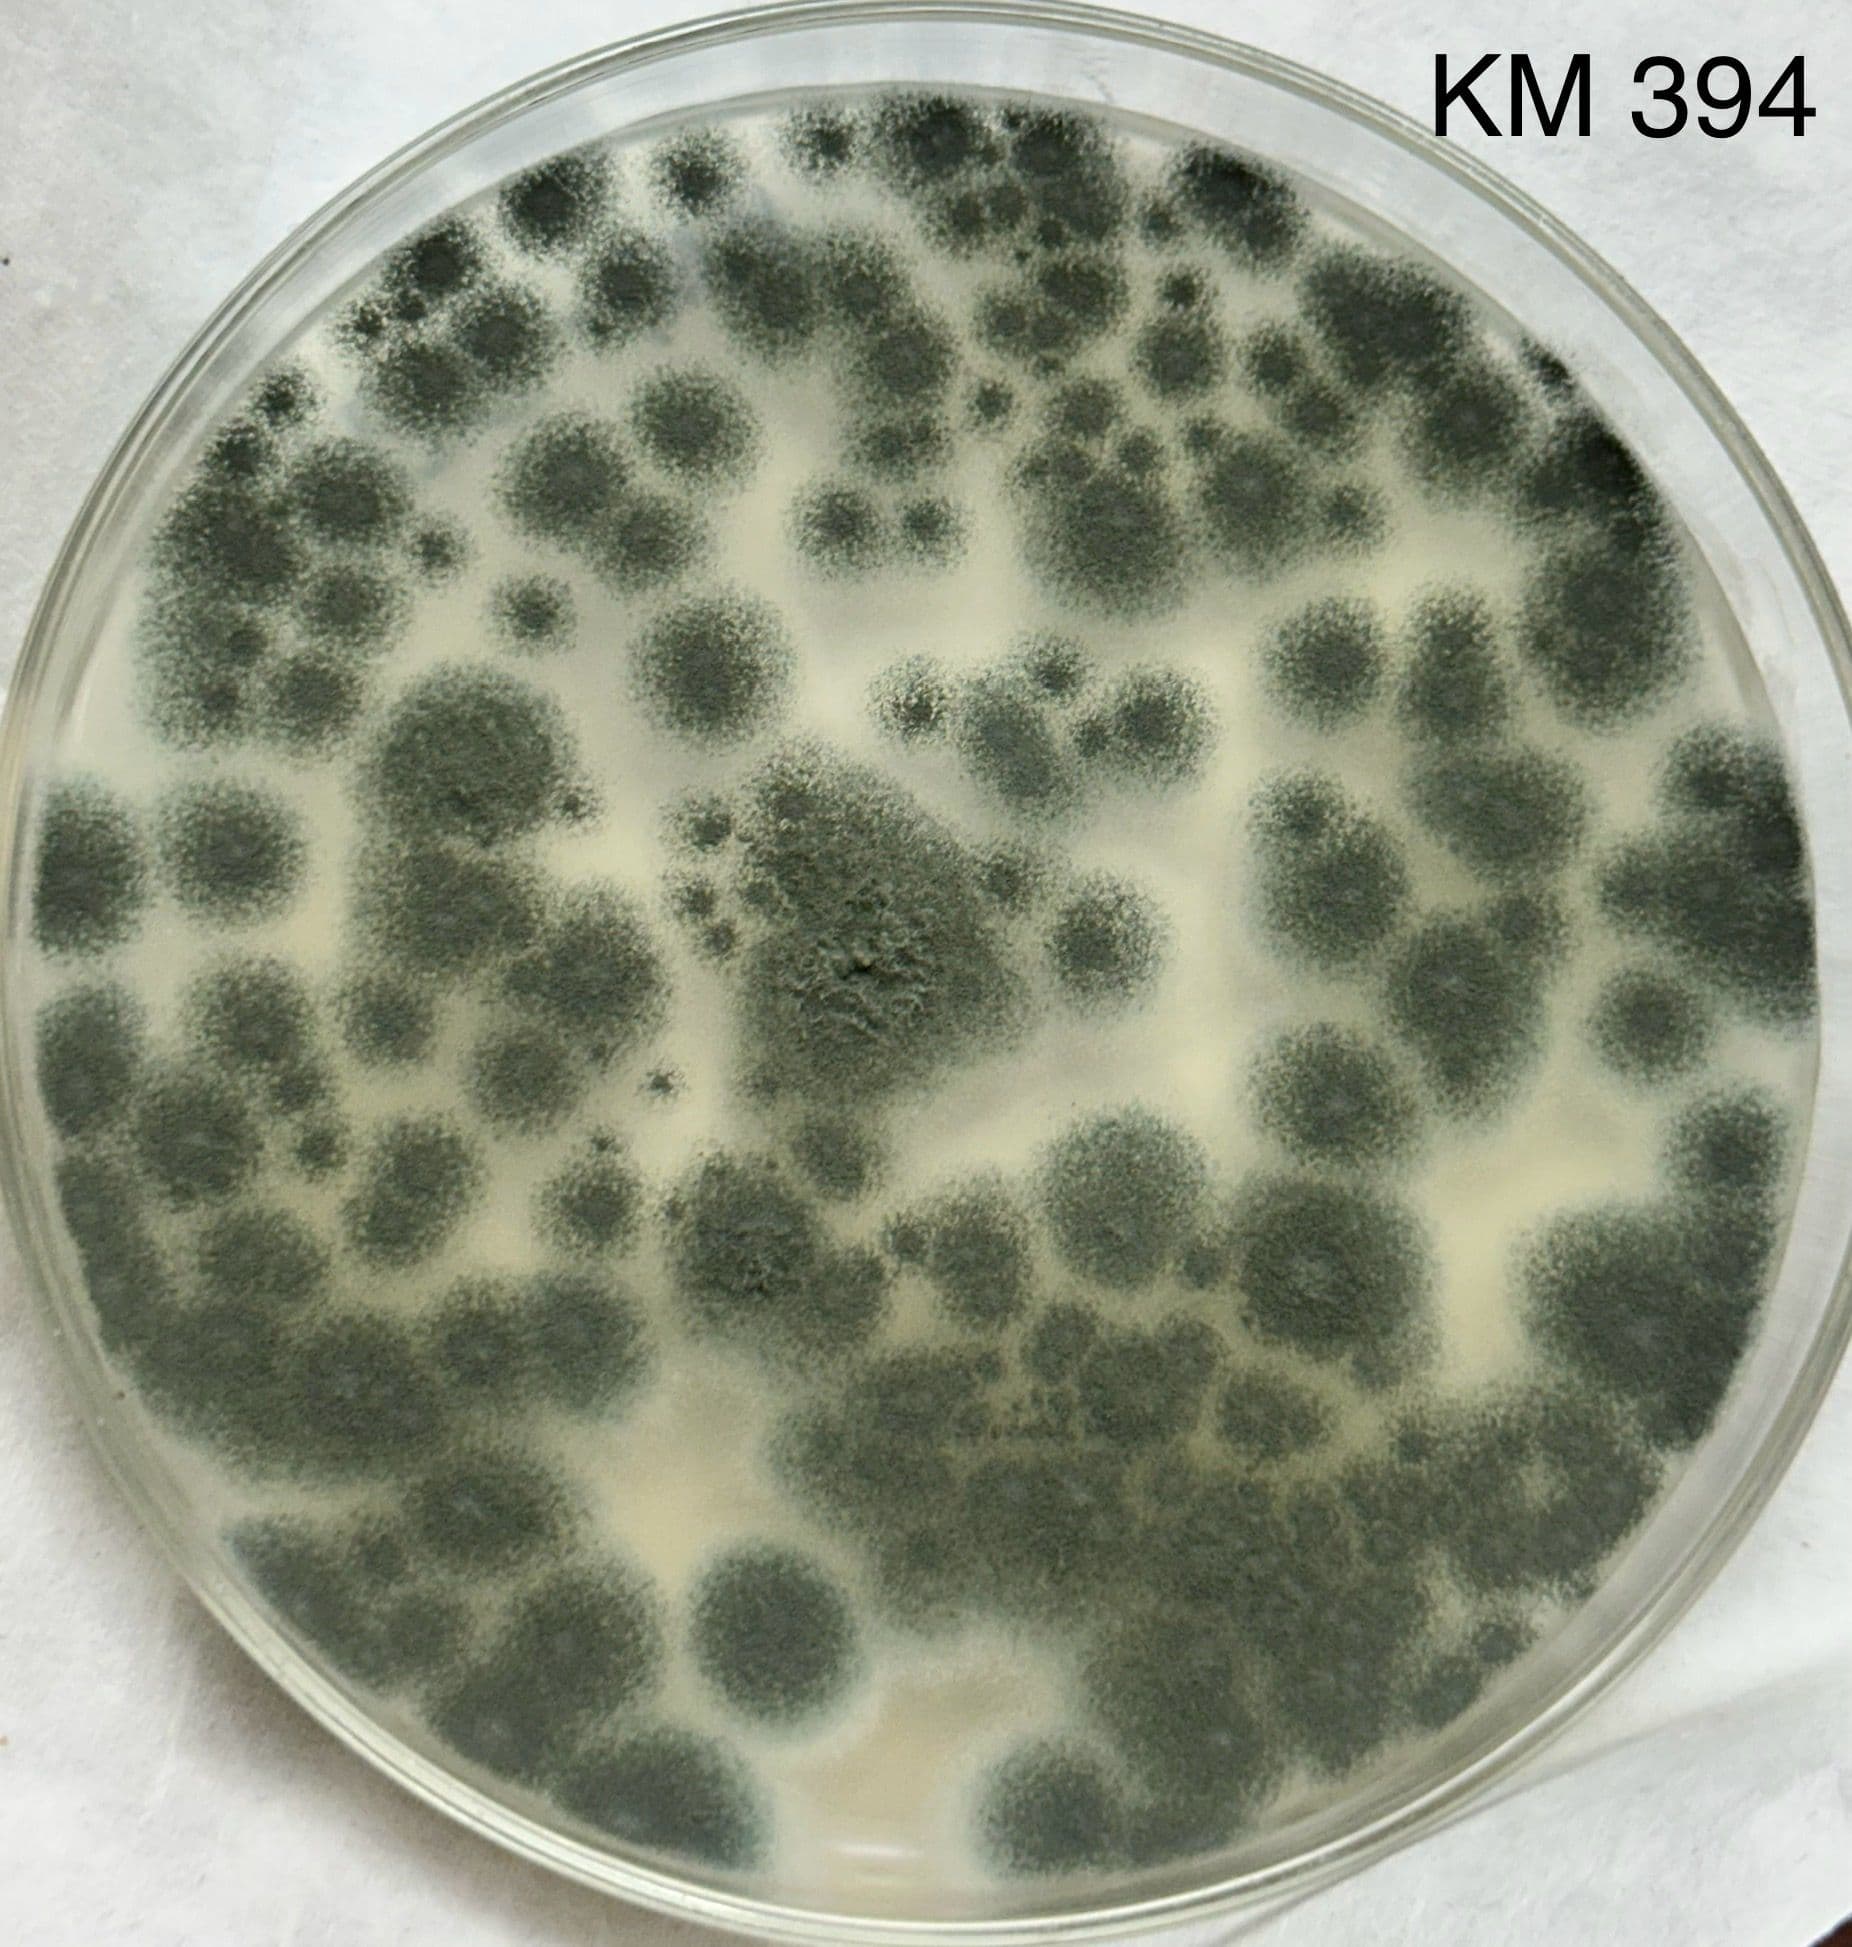
Large Petri dish with extensive microbial growth
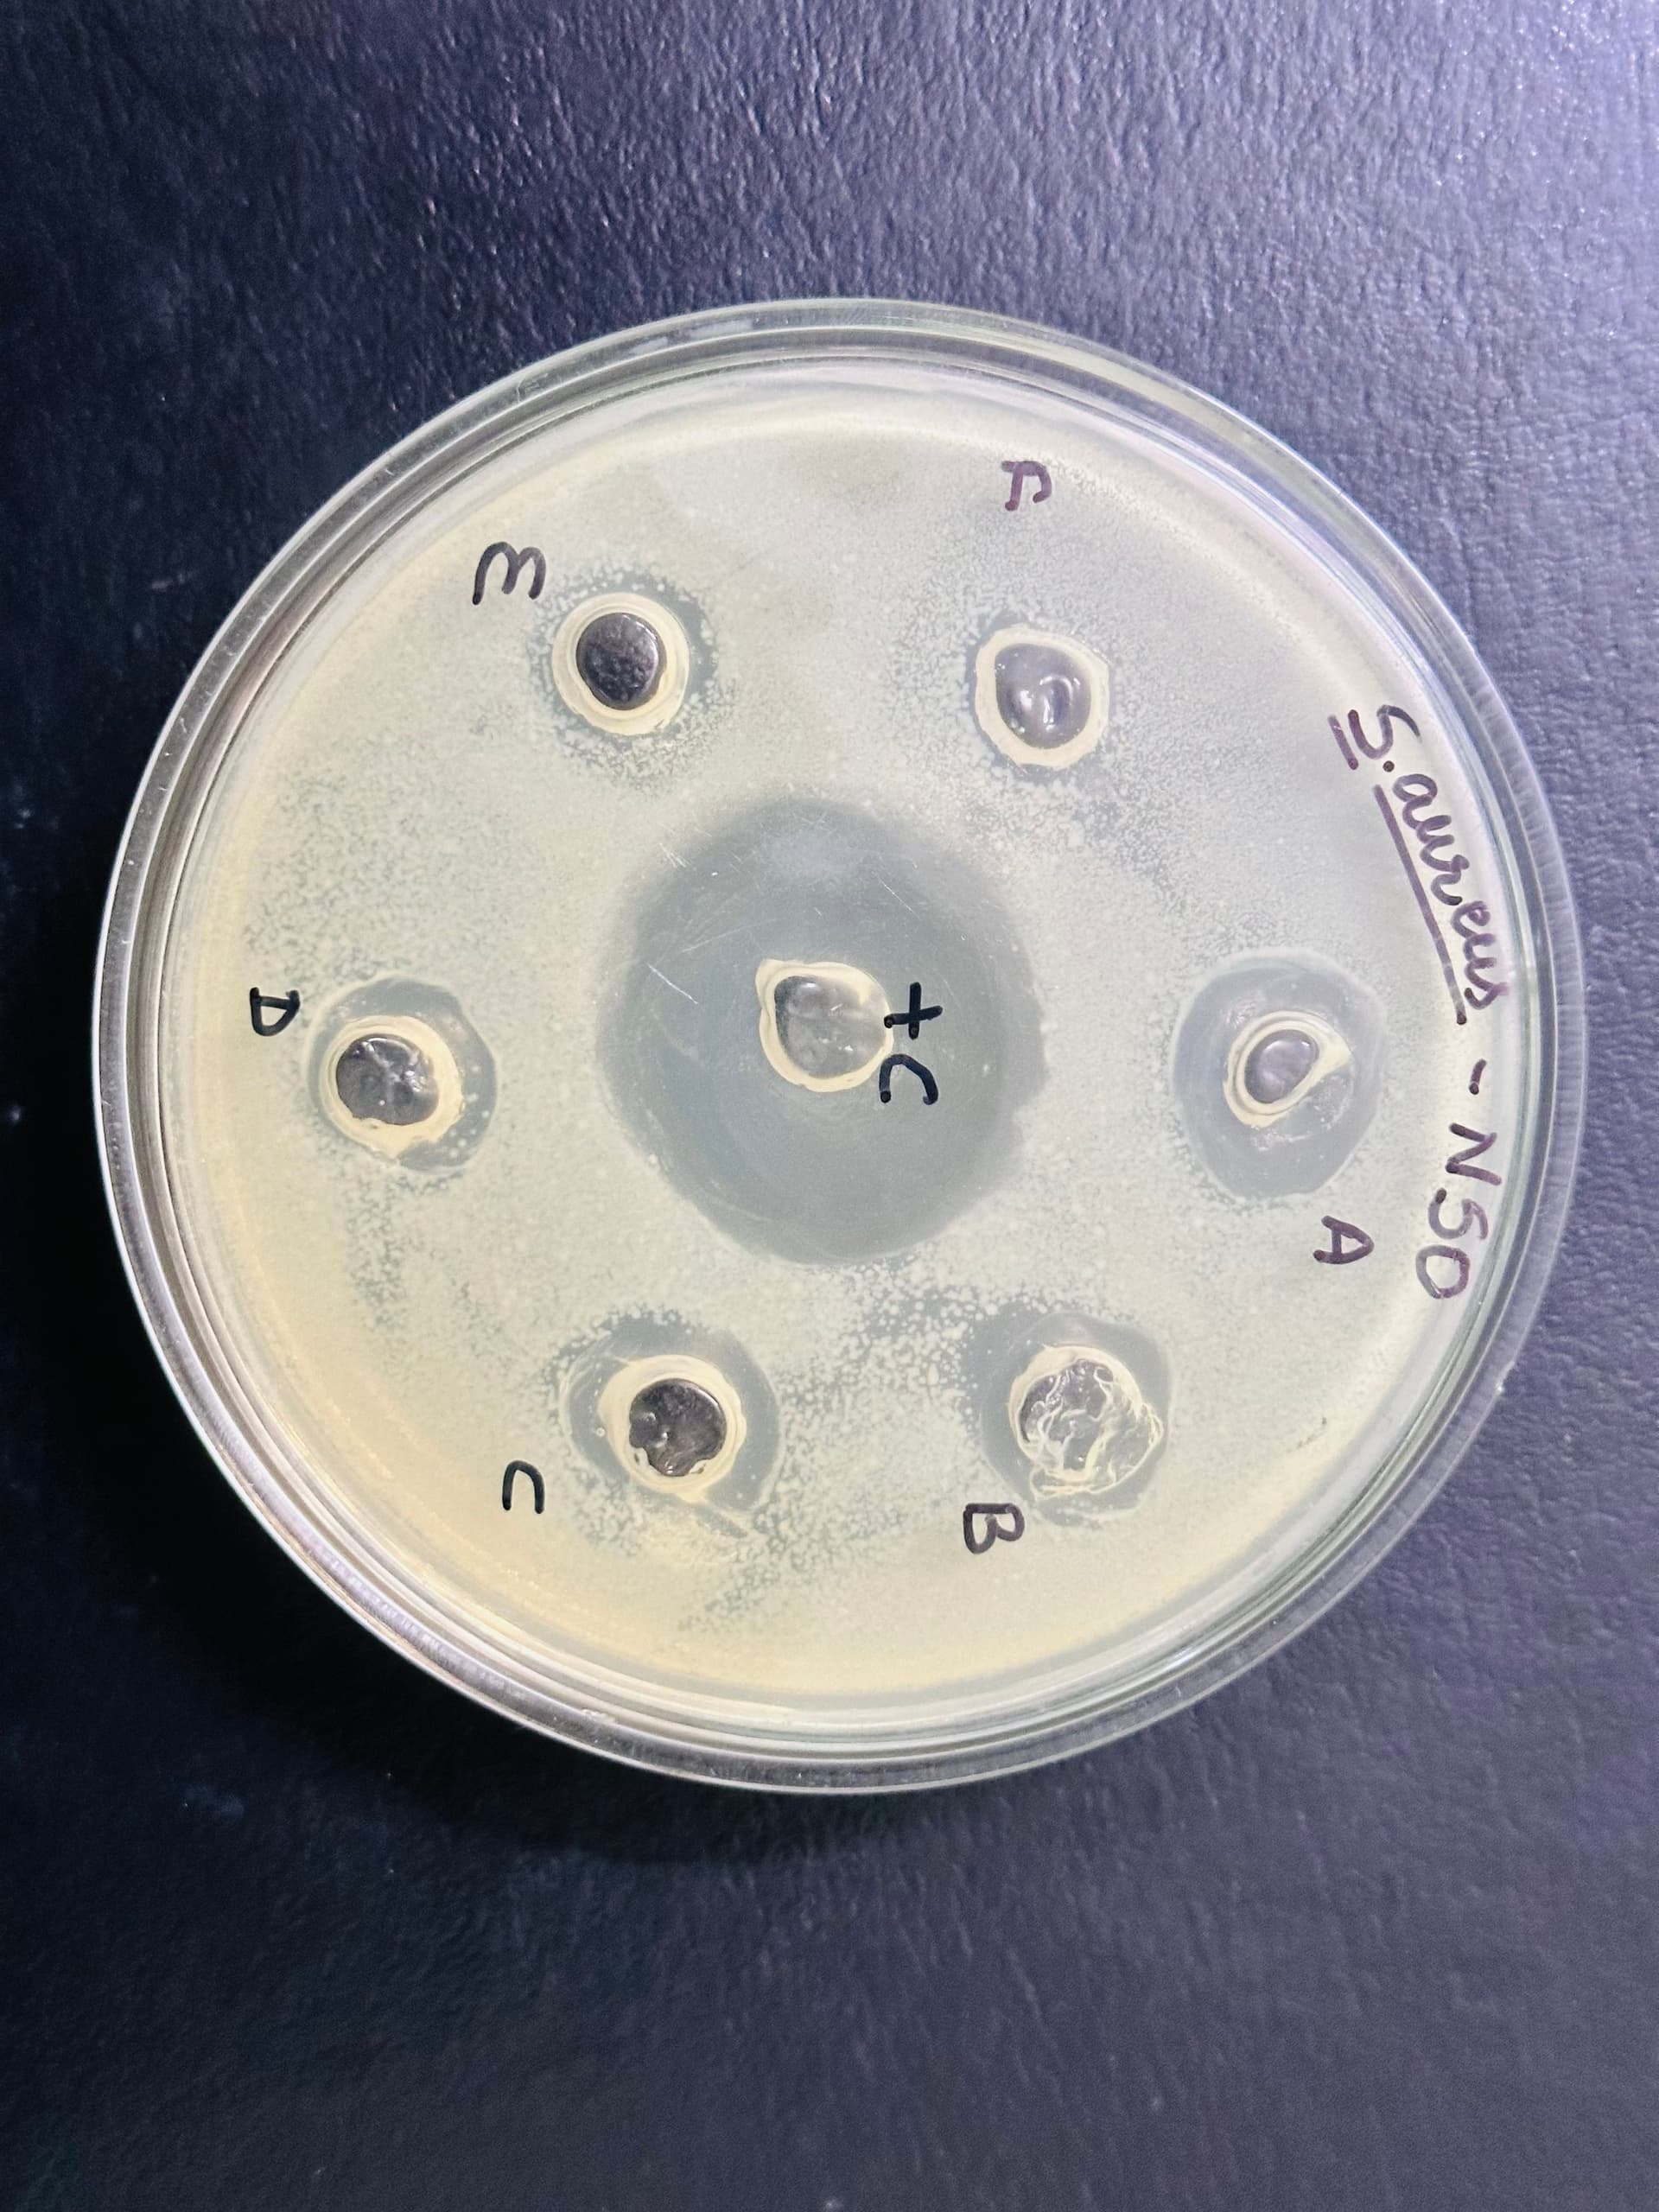
Zones of clearance on a bacterial agar plate
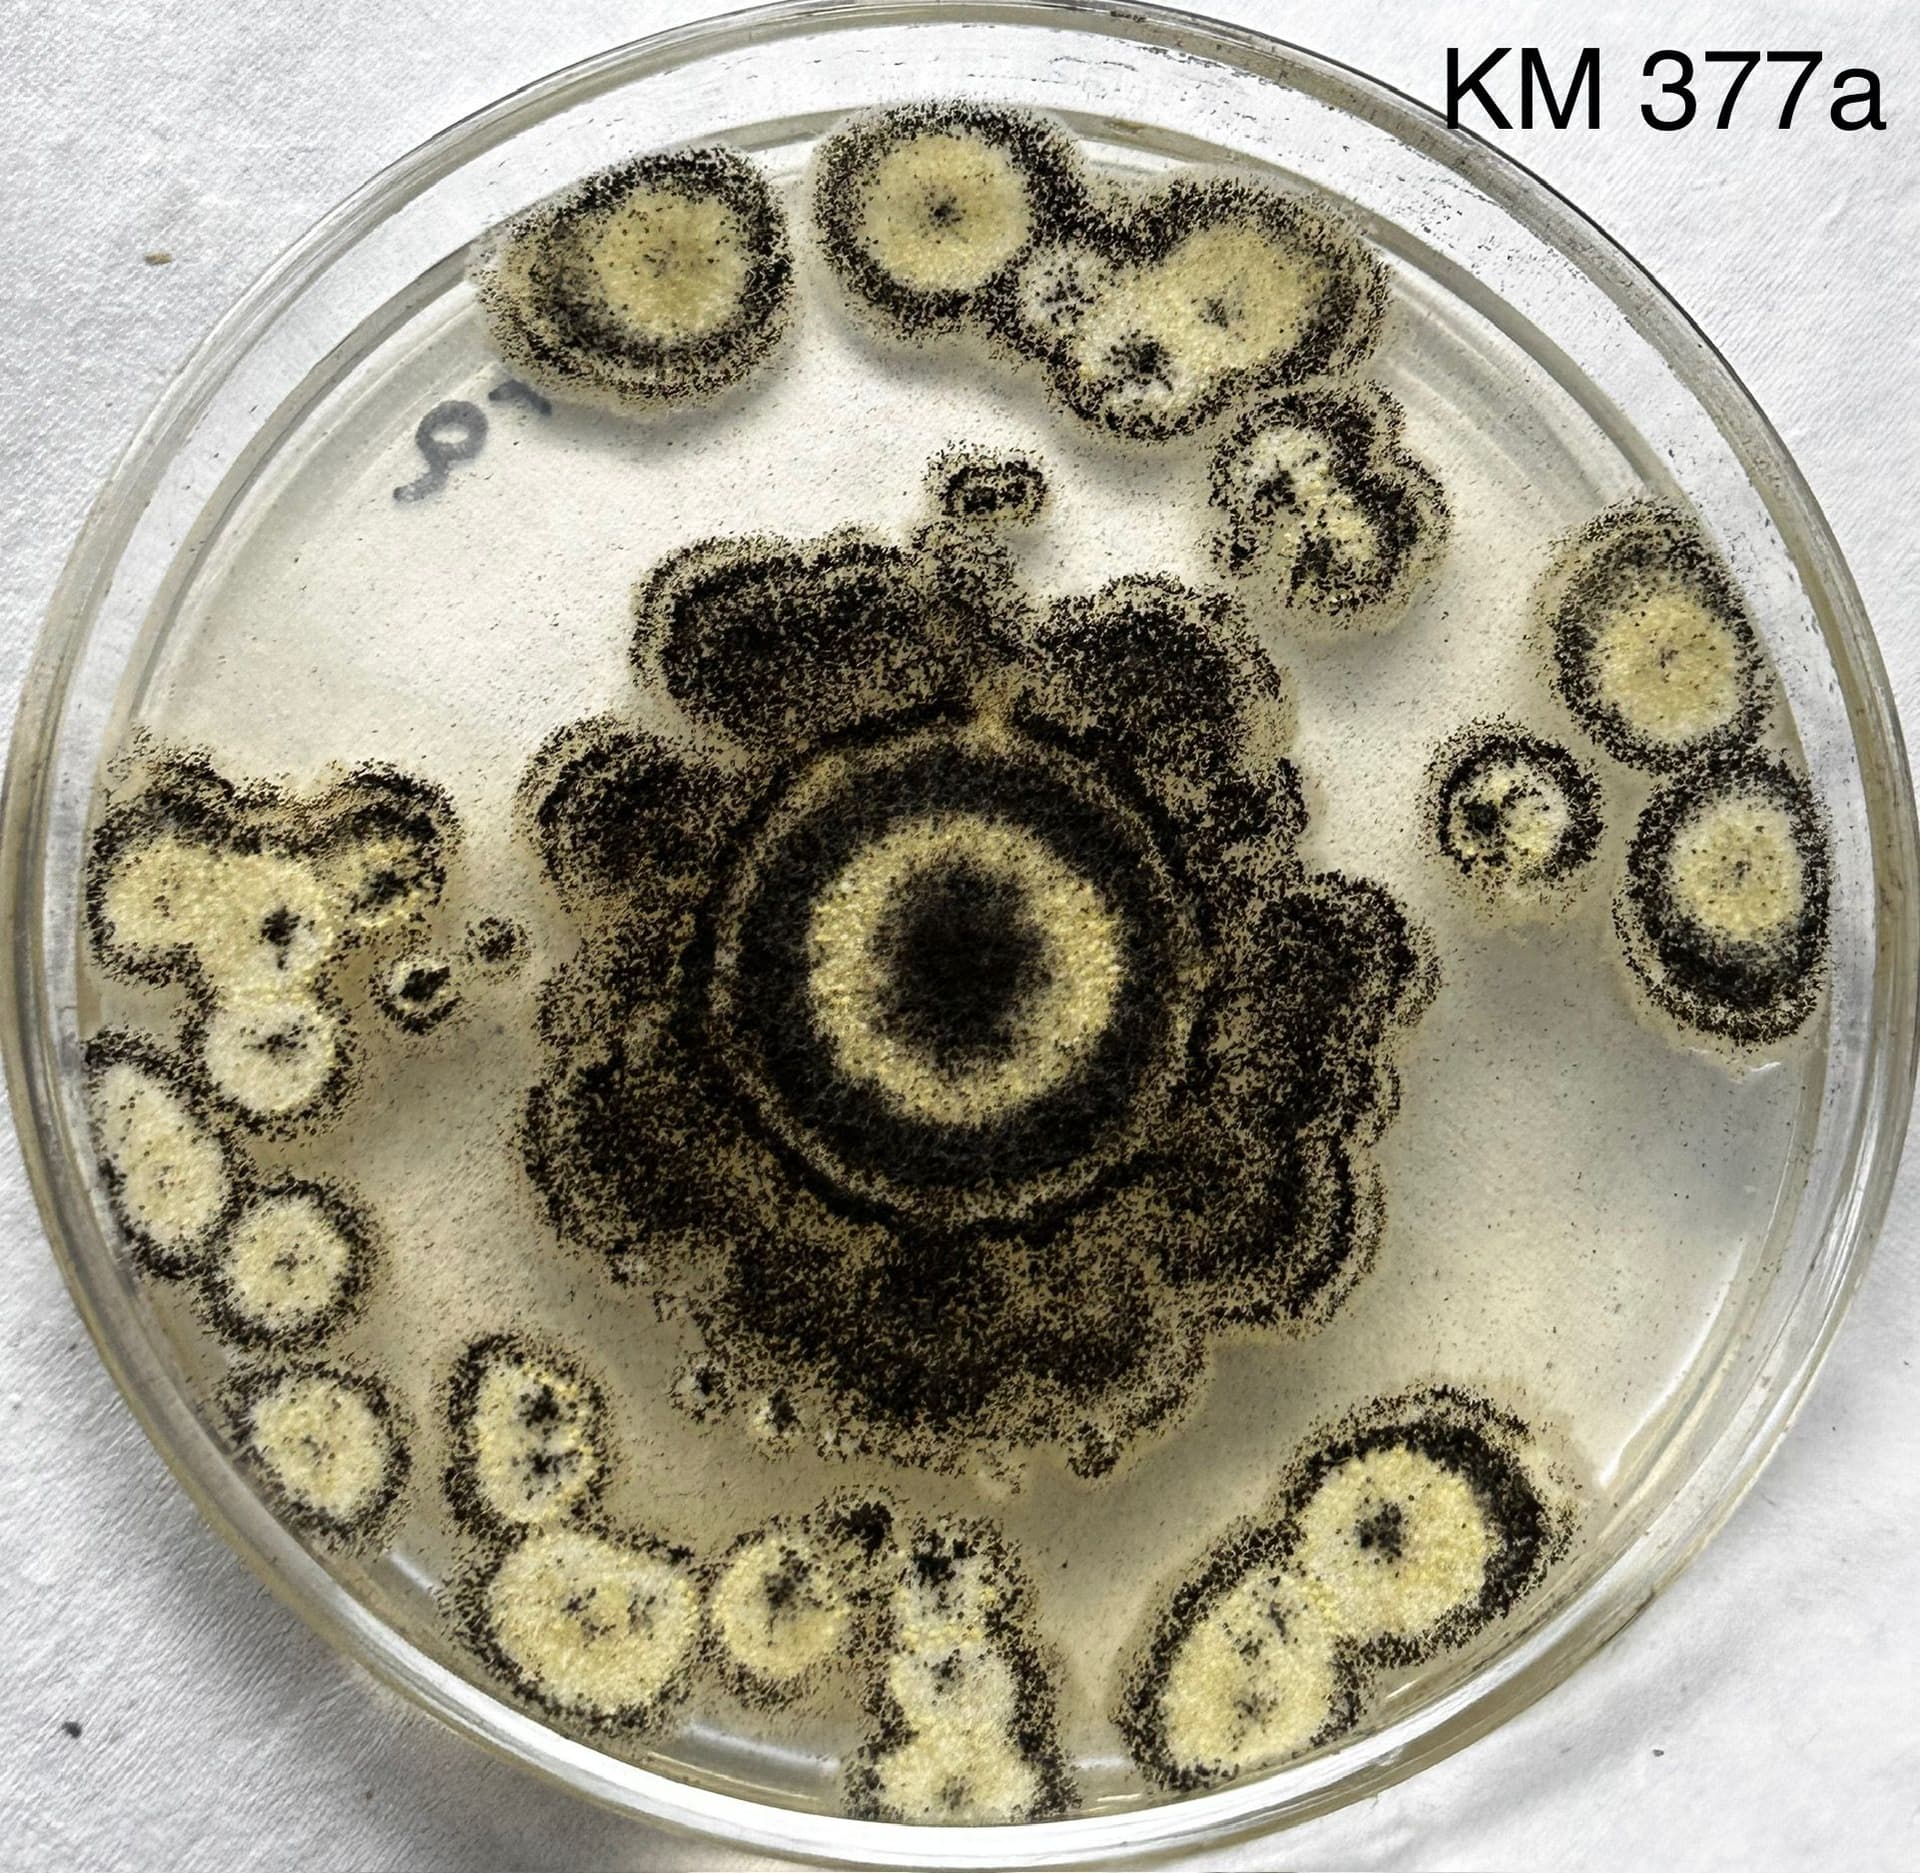
Elaborate fungal colony morphology on solid media
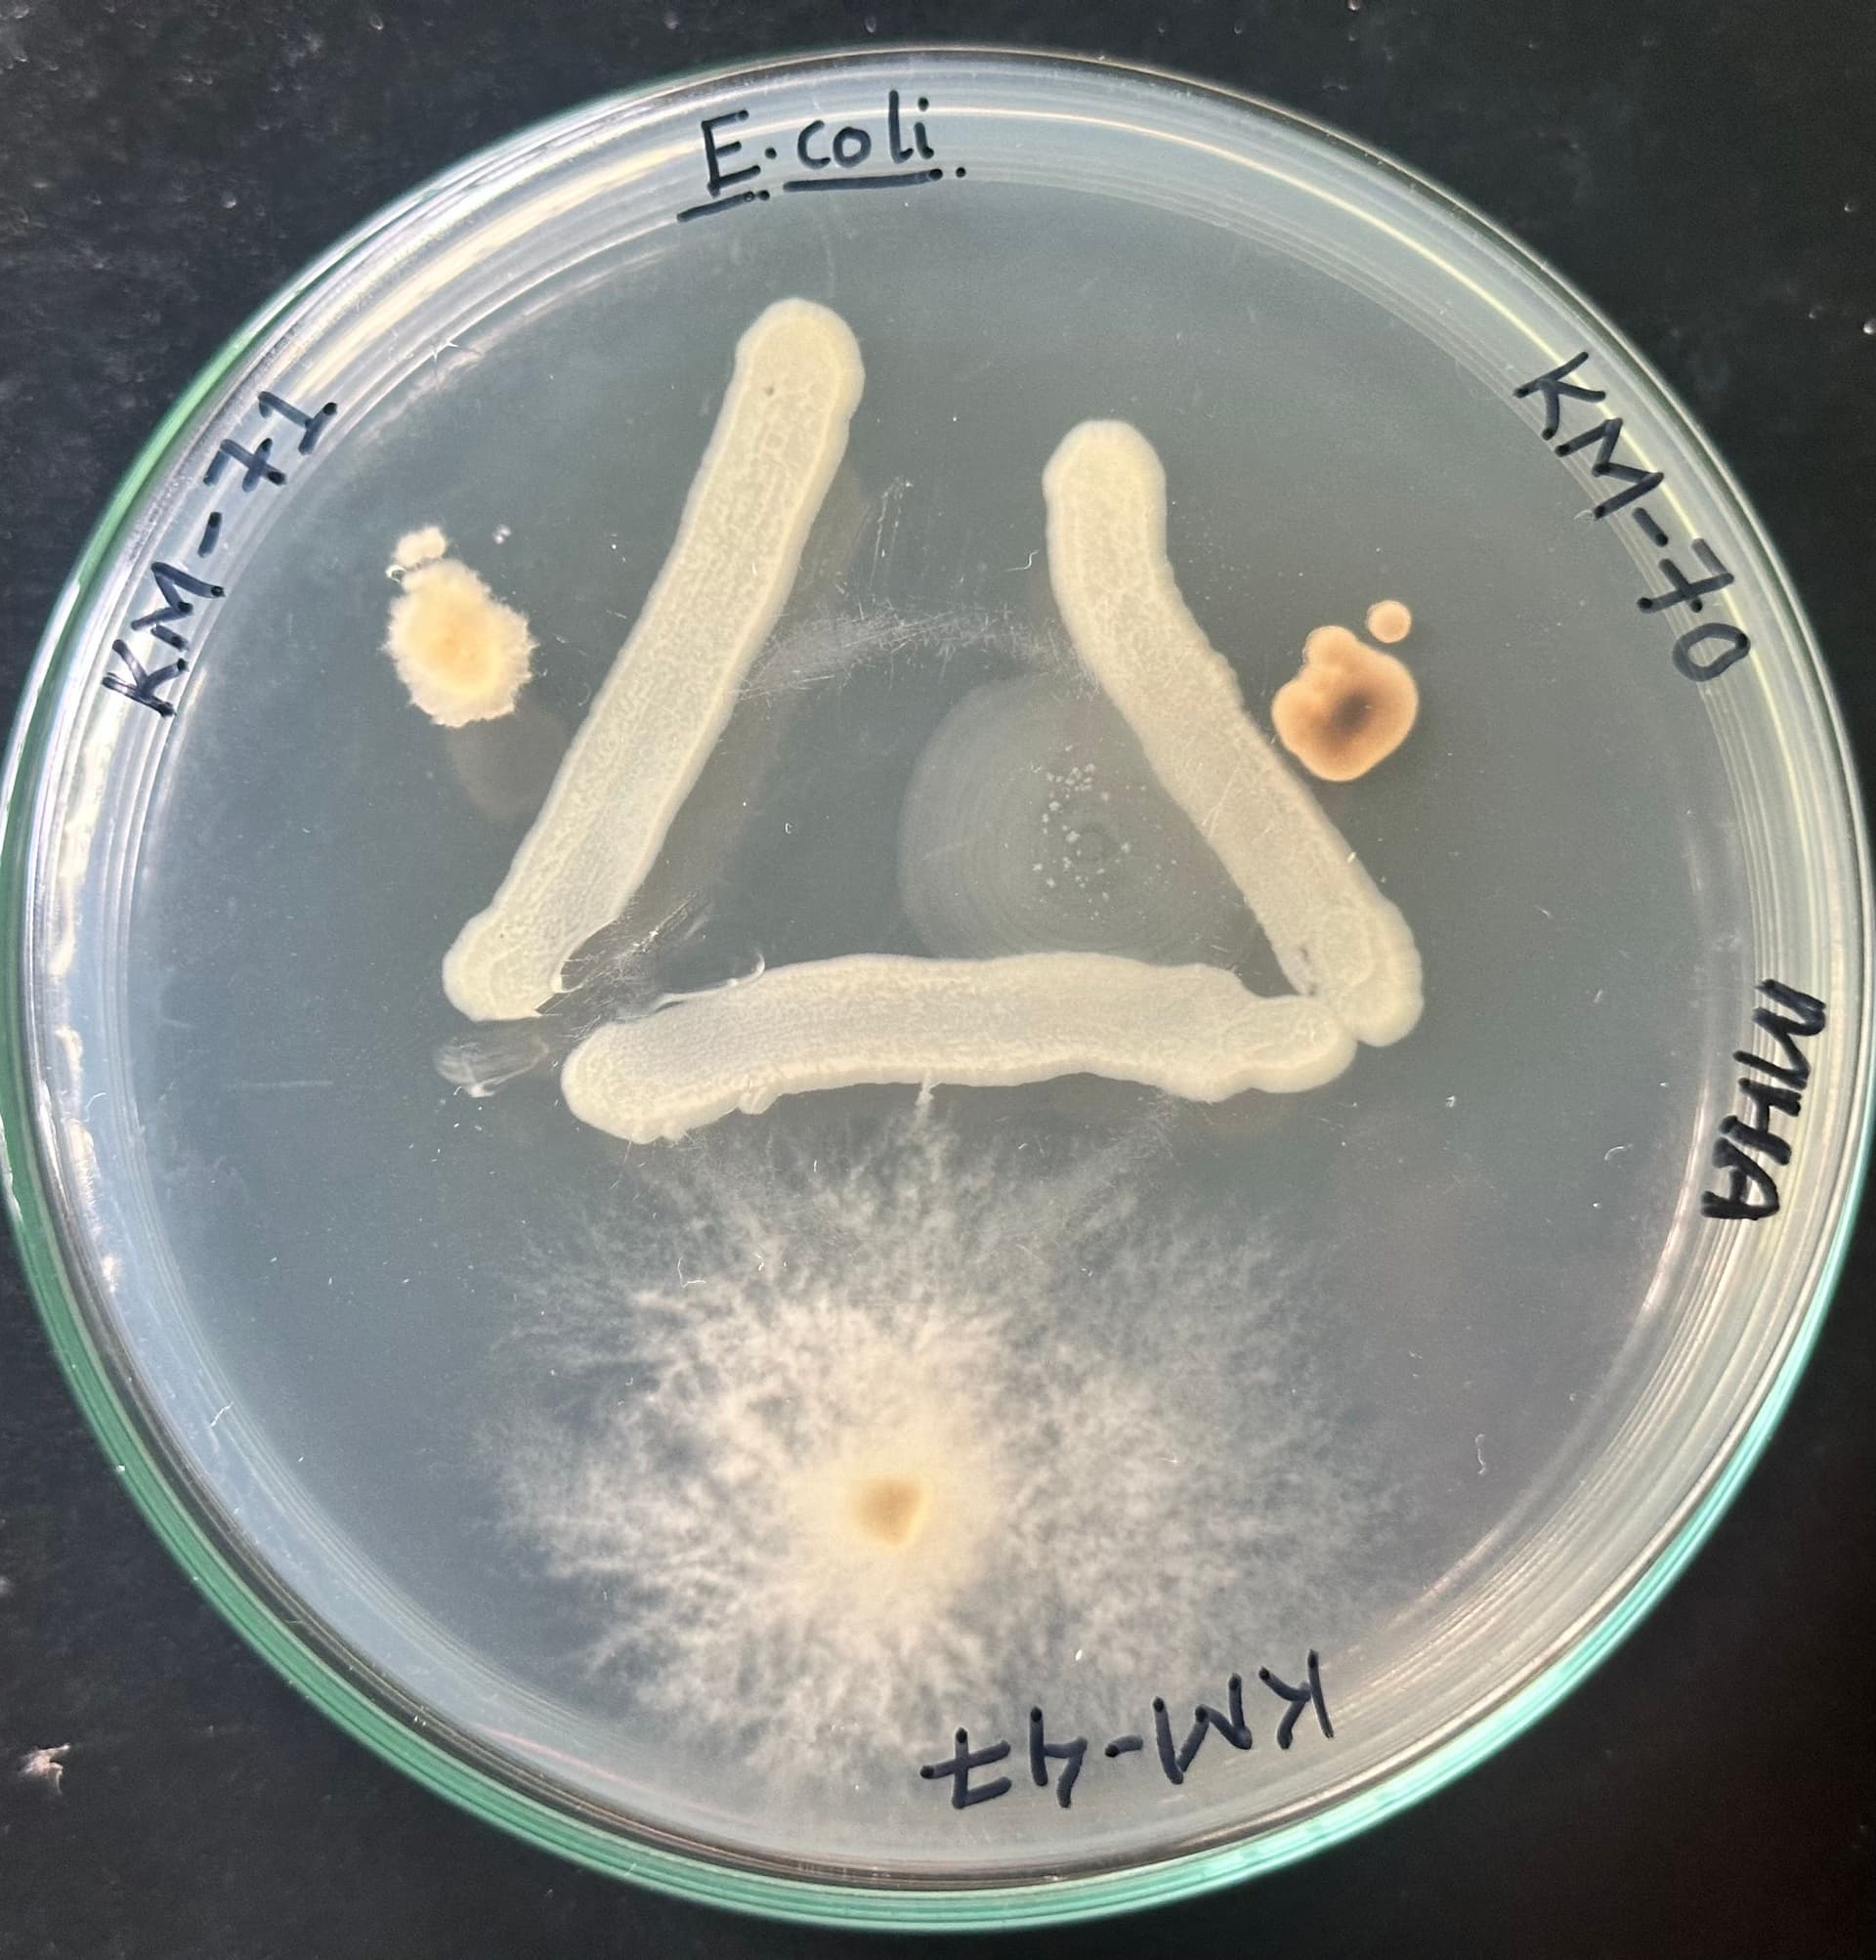
Microbial interaction study on a Petri dish
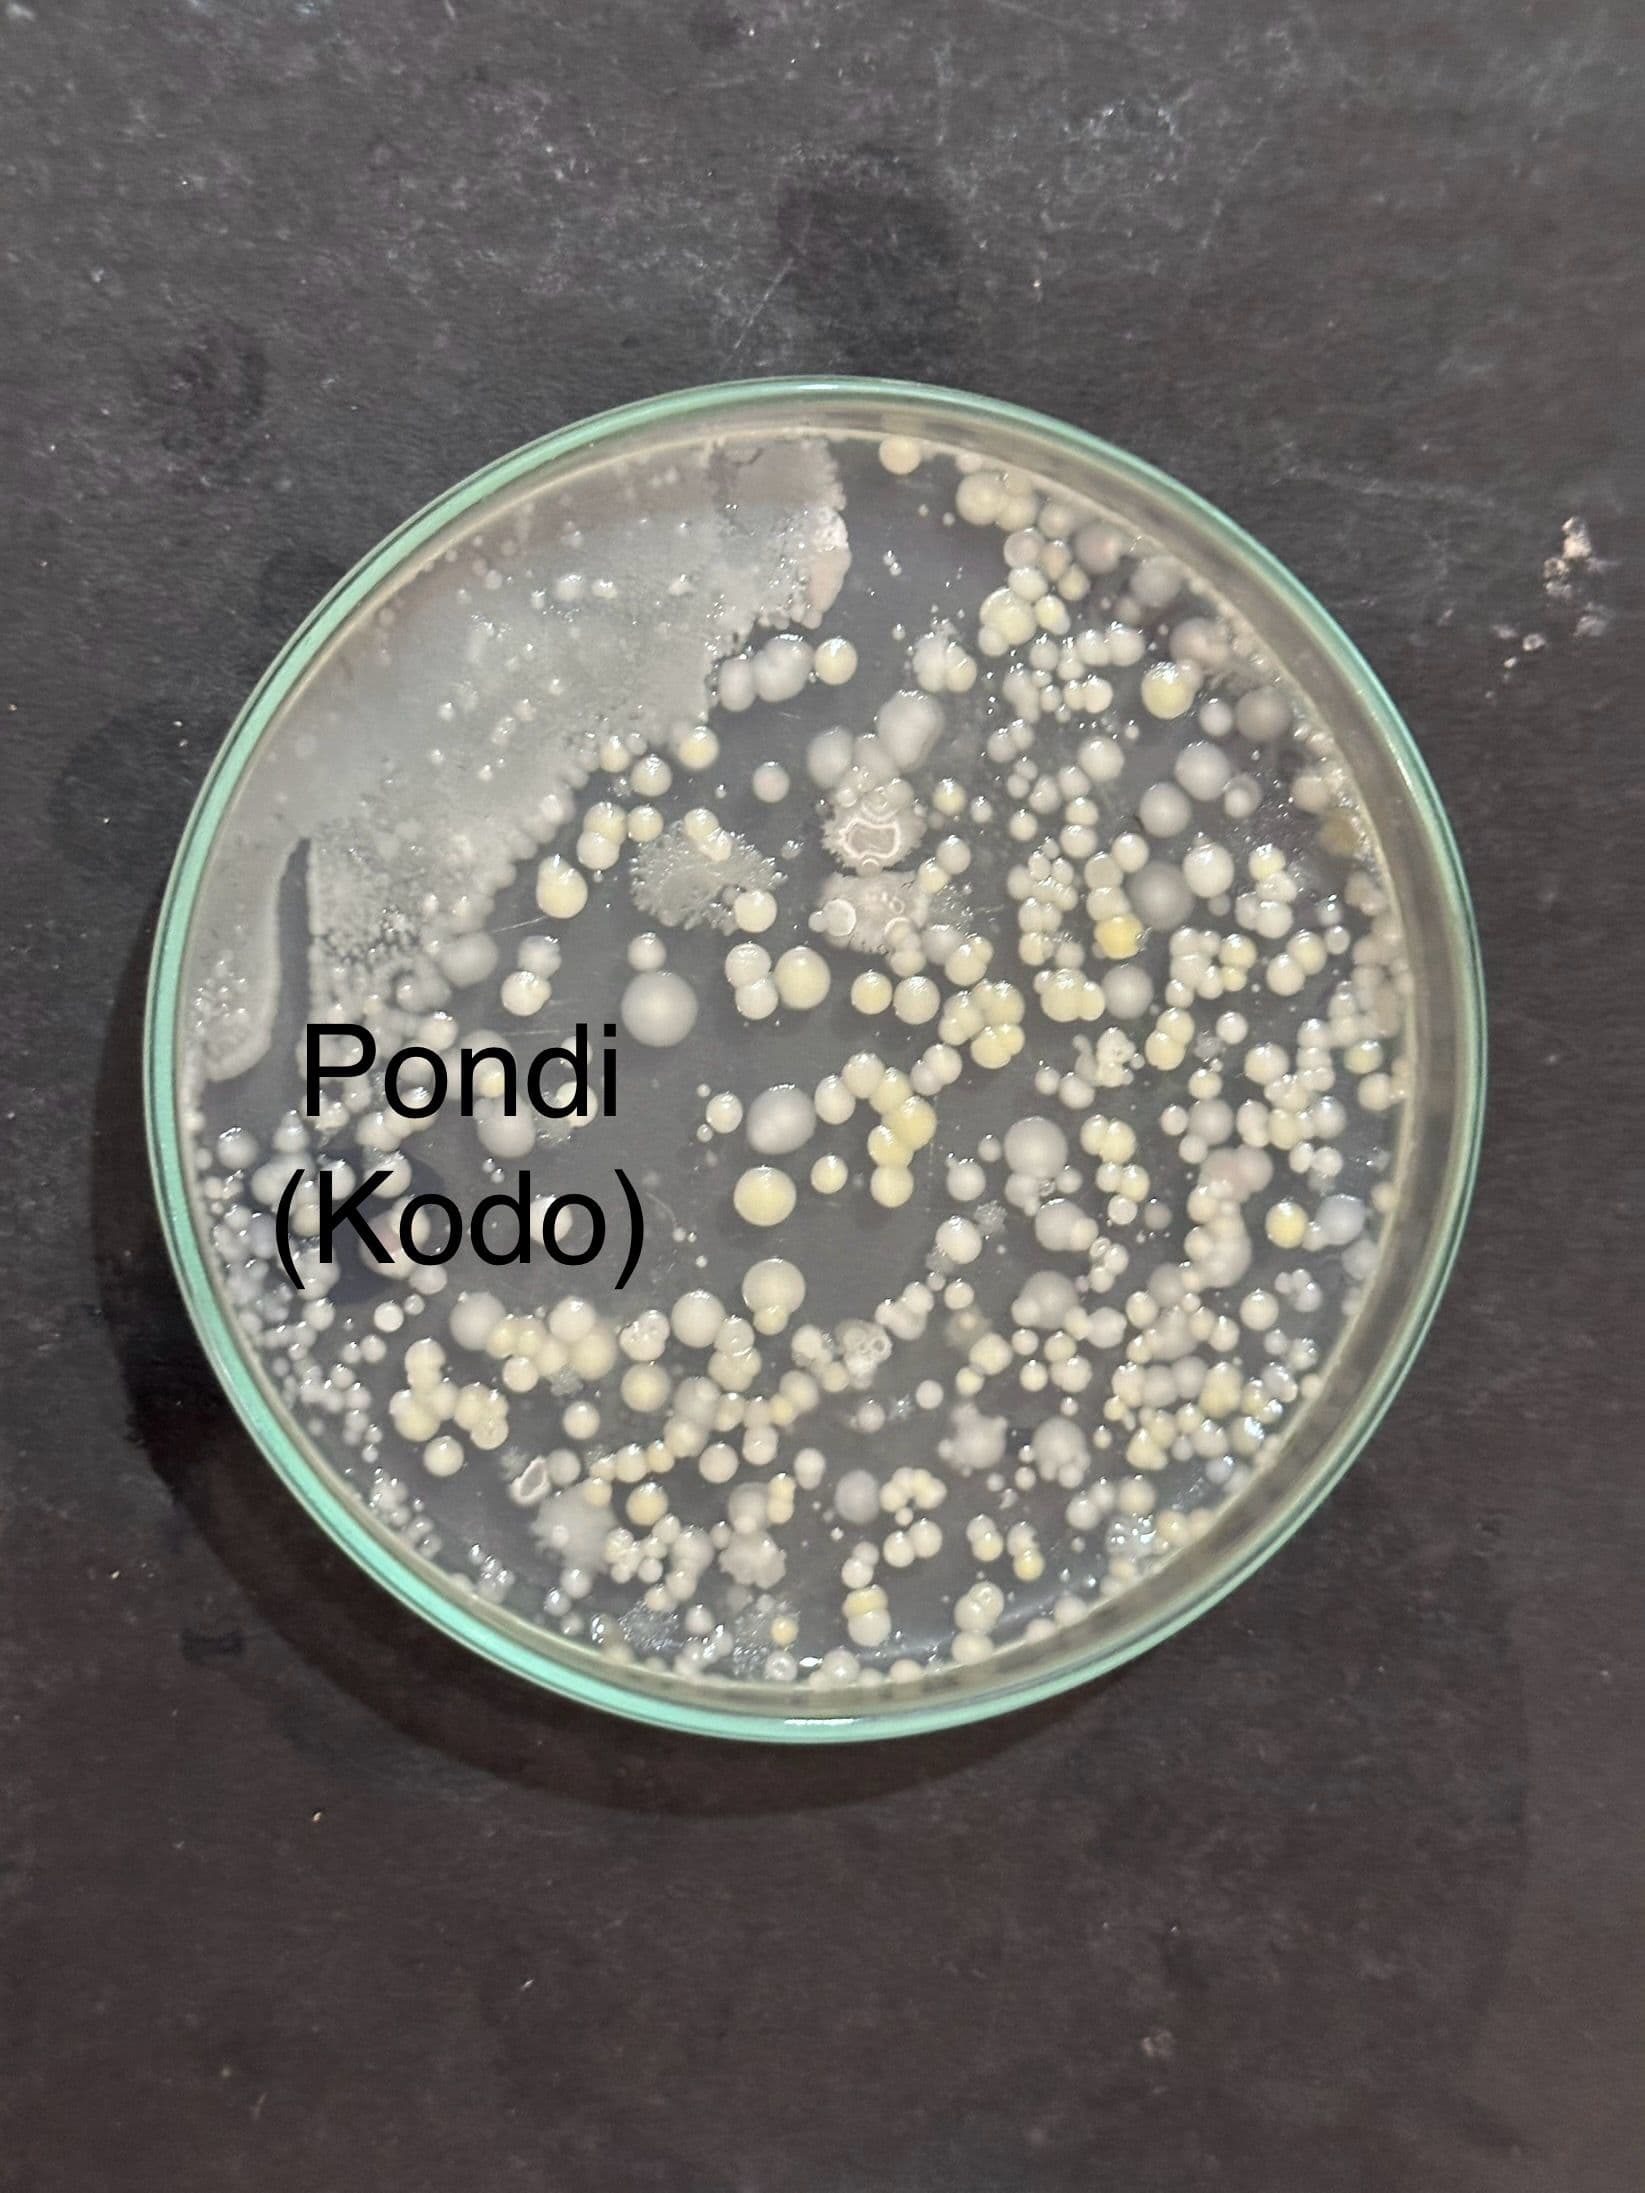
Bacterial culture identified as Kodo research
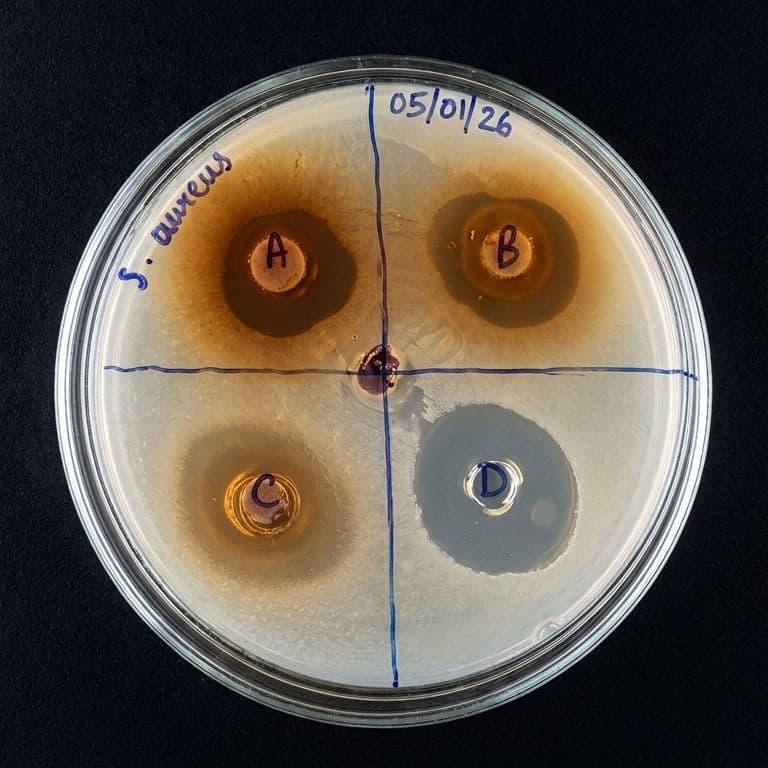
Microbial colonies on a Petri dish in a laboratory setting
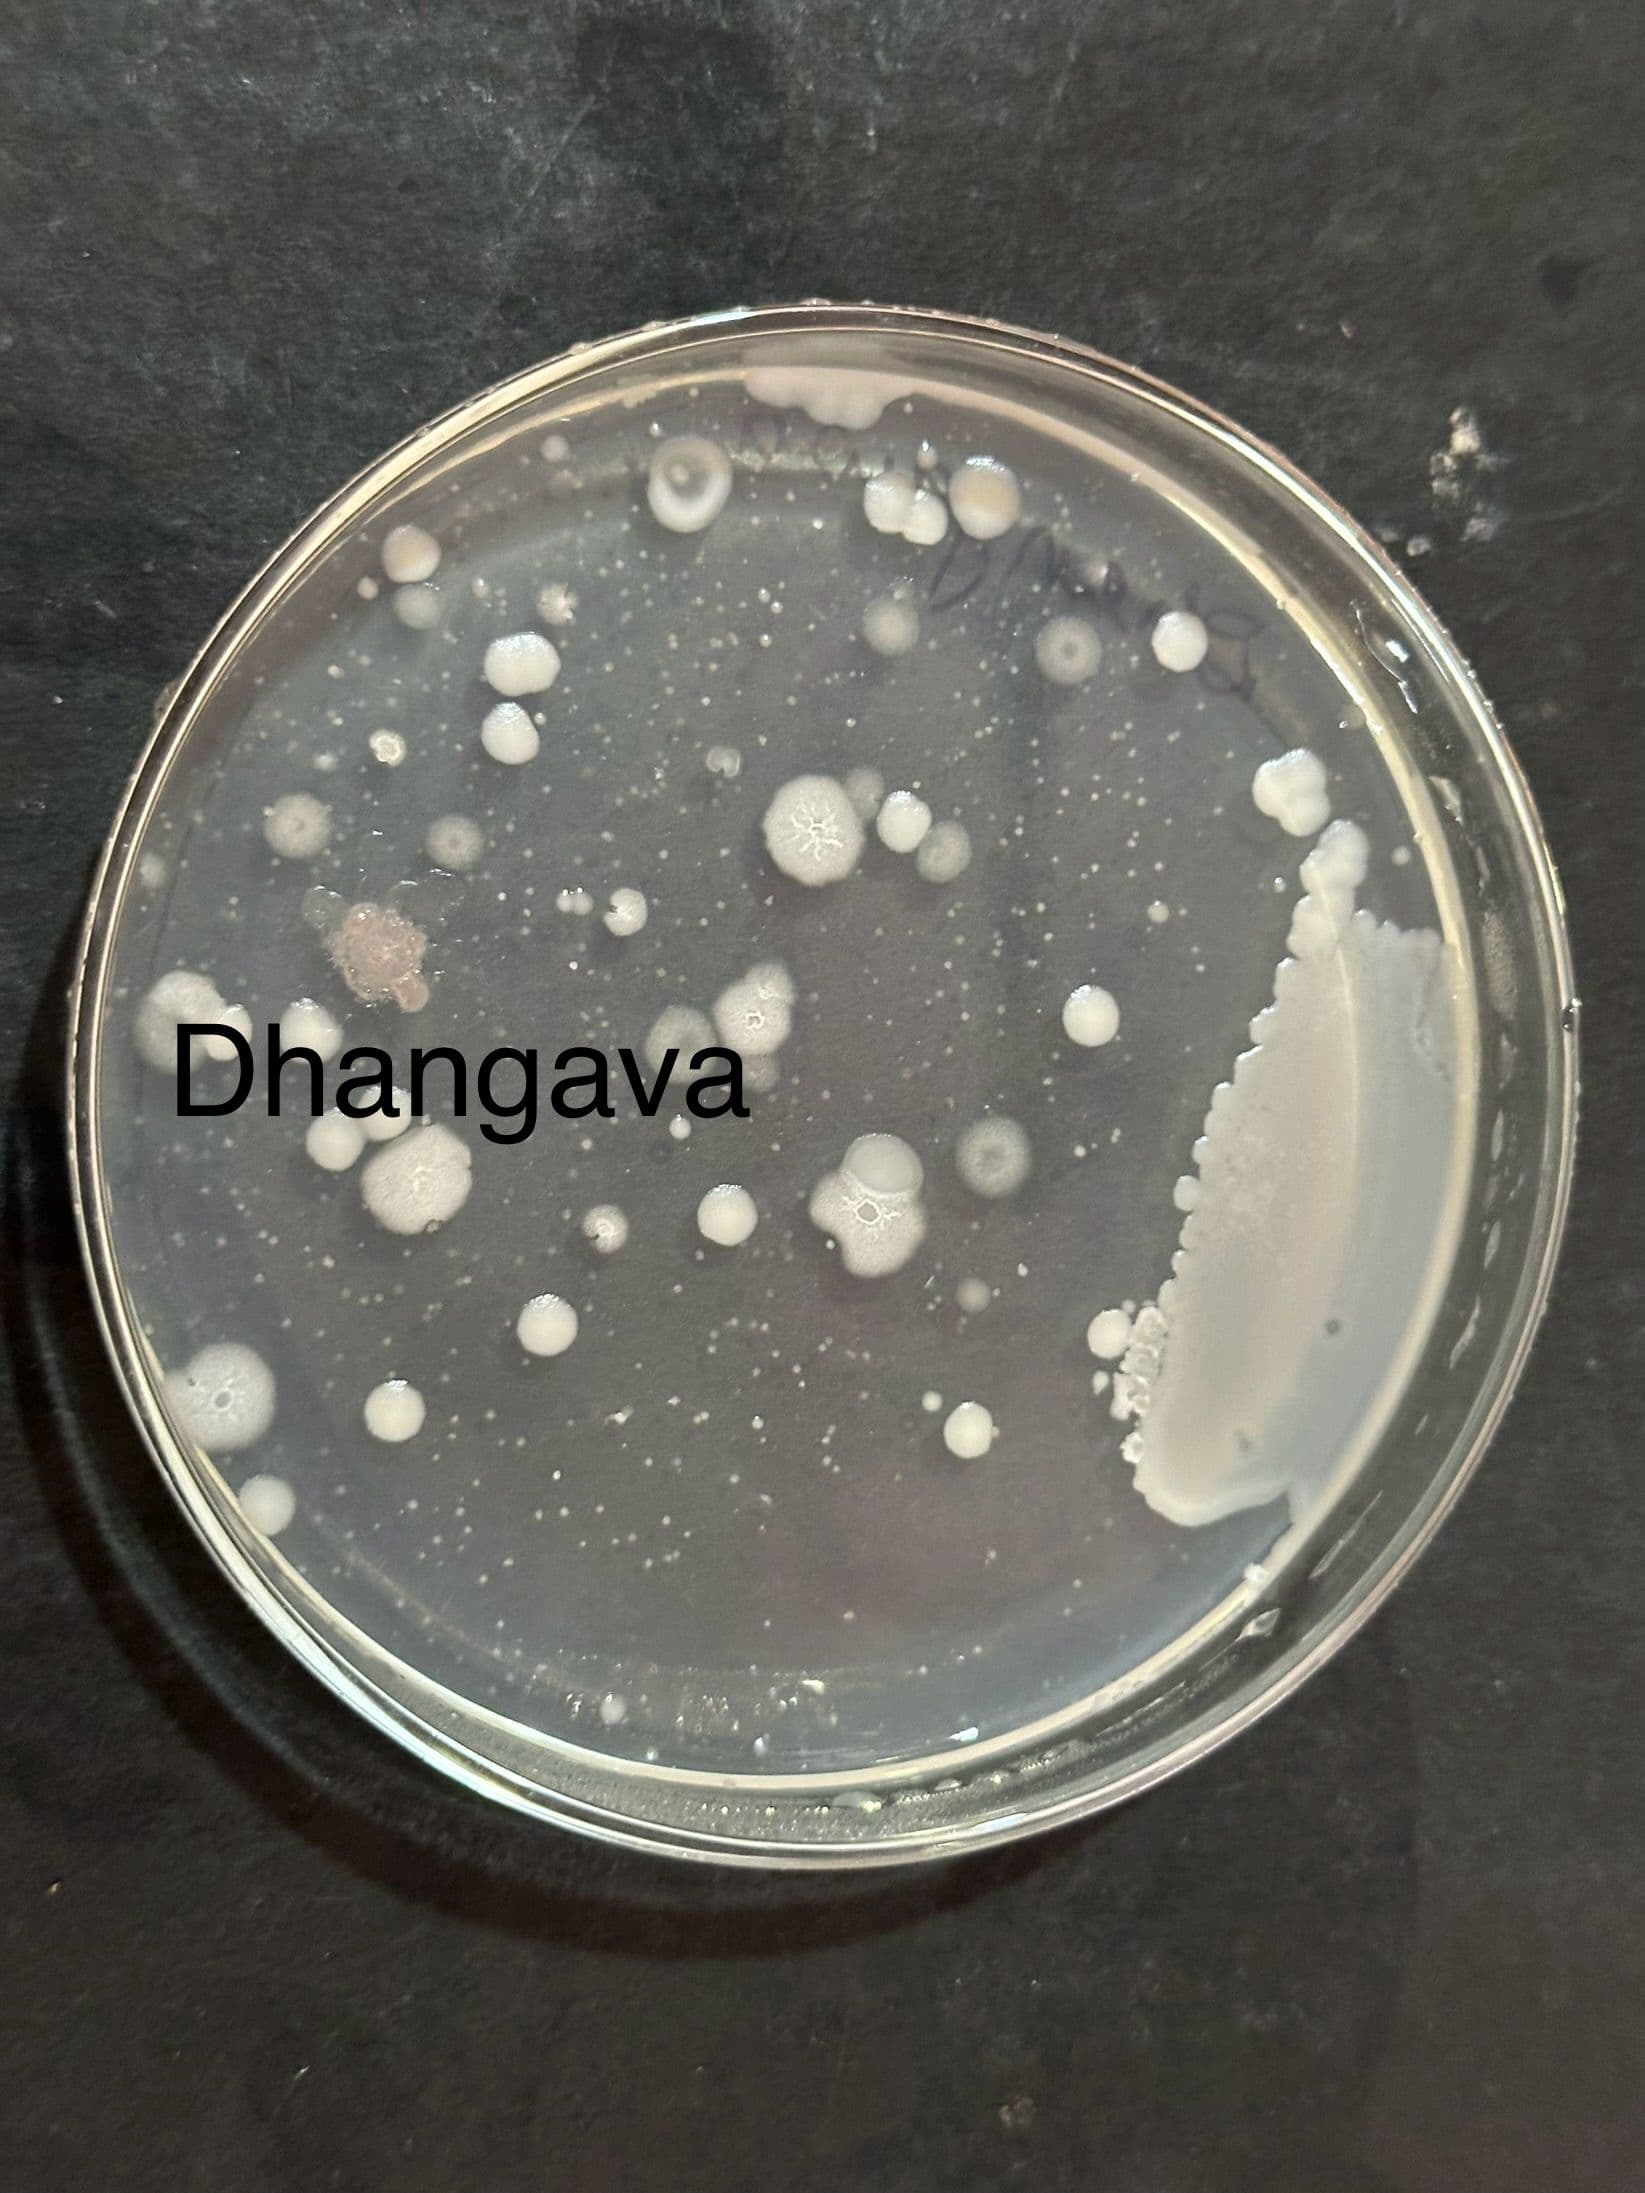
Agar plate labeled Dhangava with multiple microbial colonies
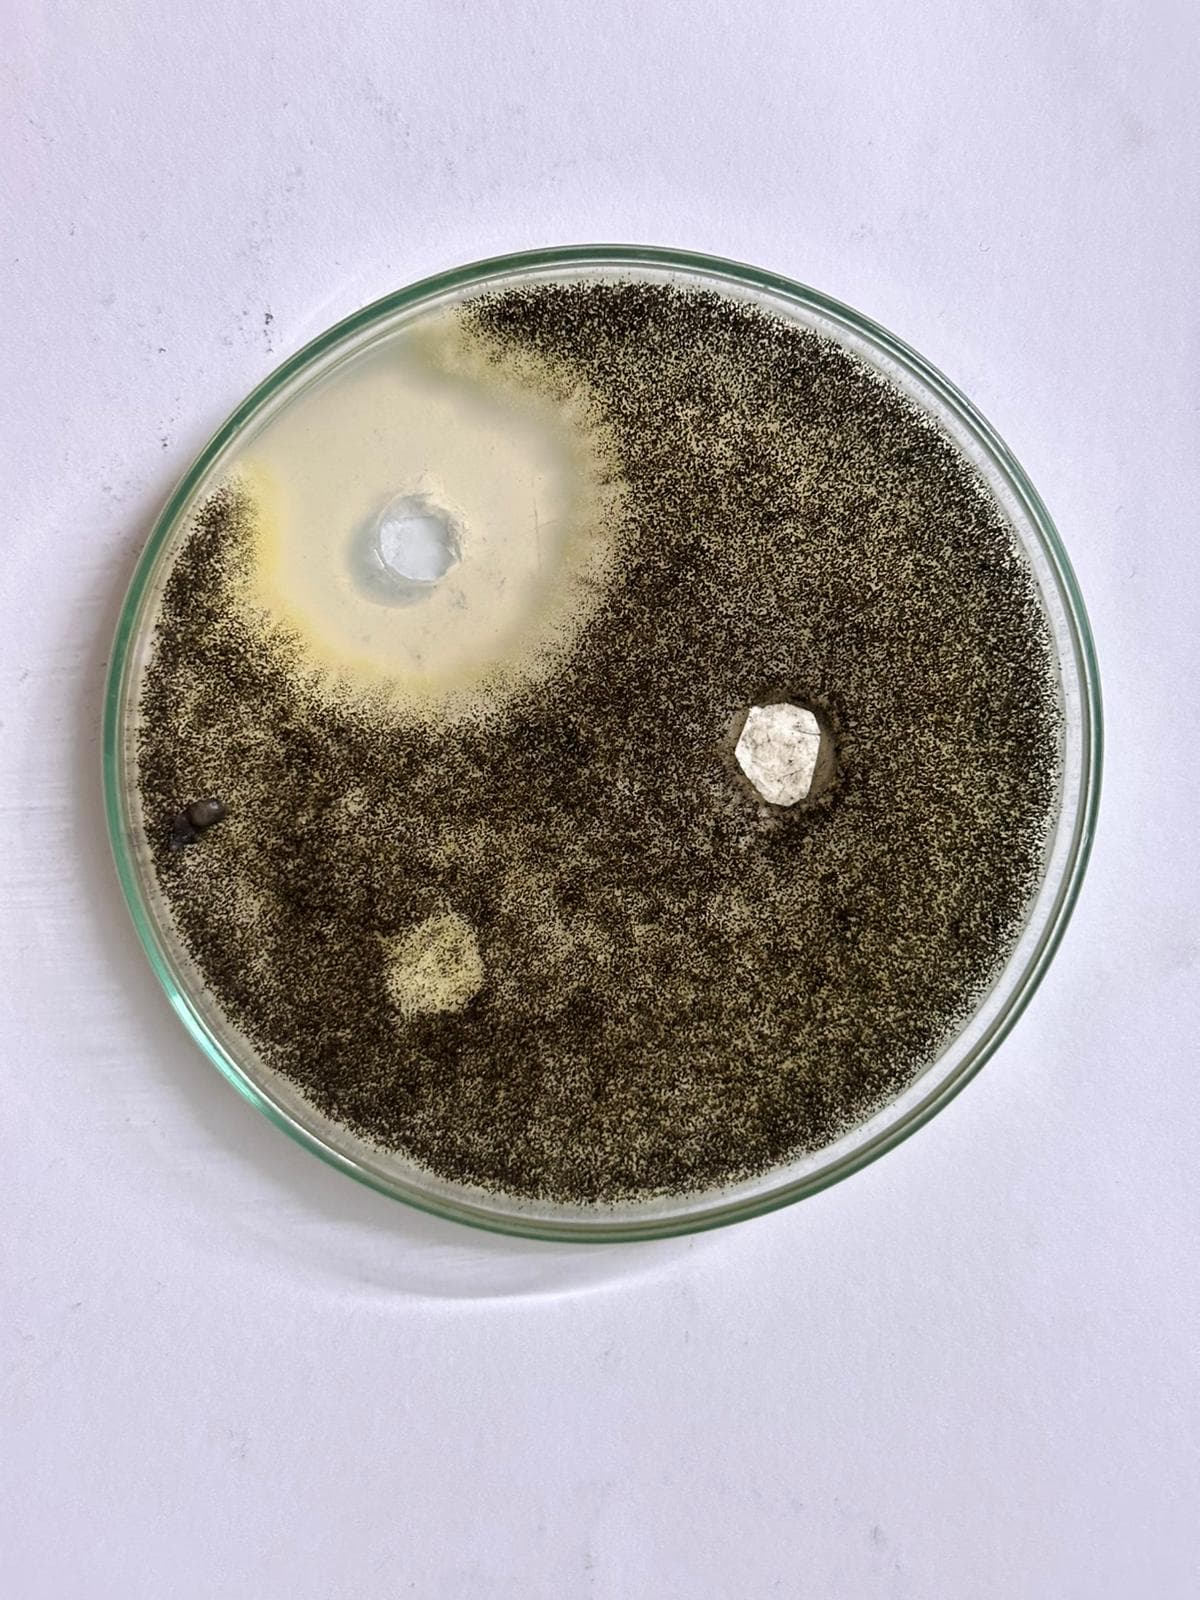
Yin-yang growth pattern of a fungal culture on a Petri dish
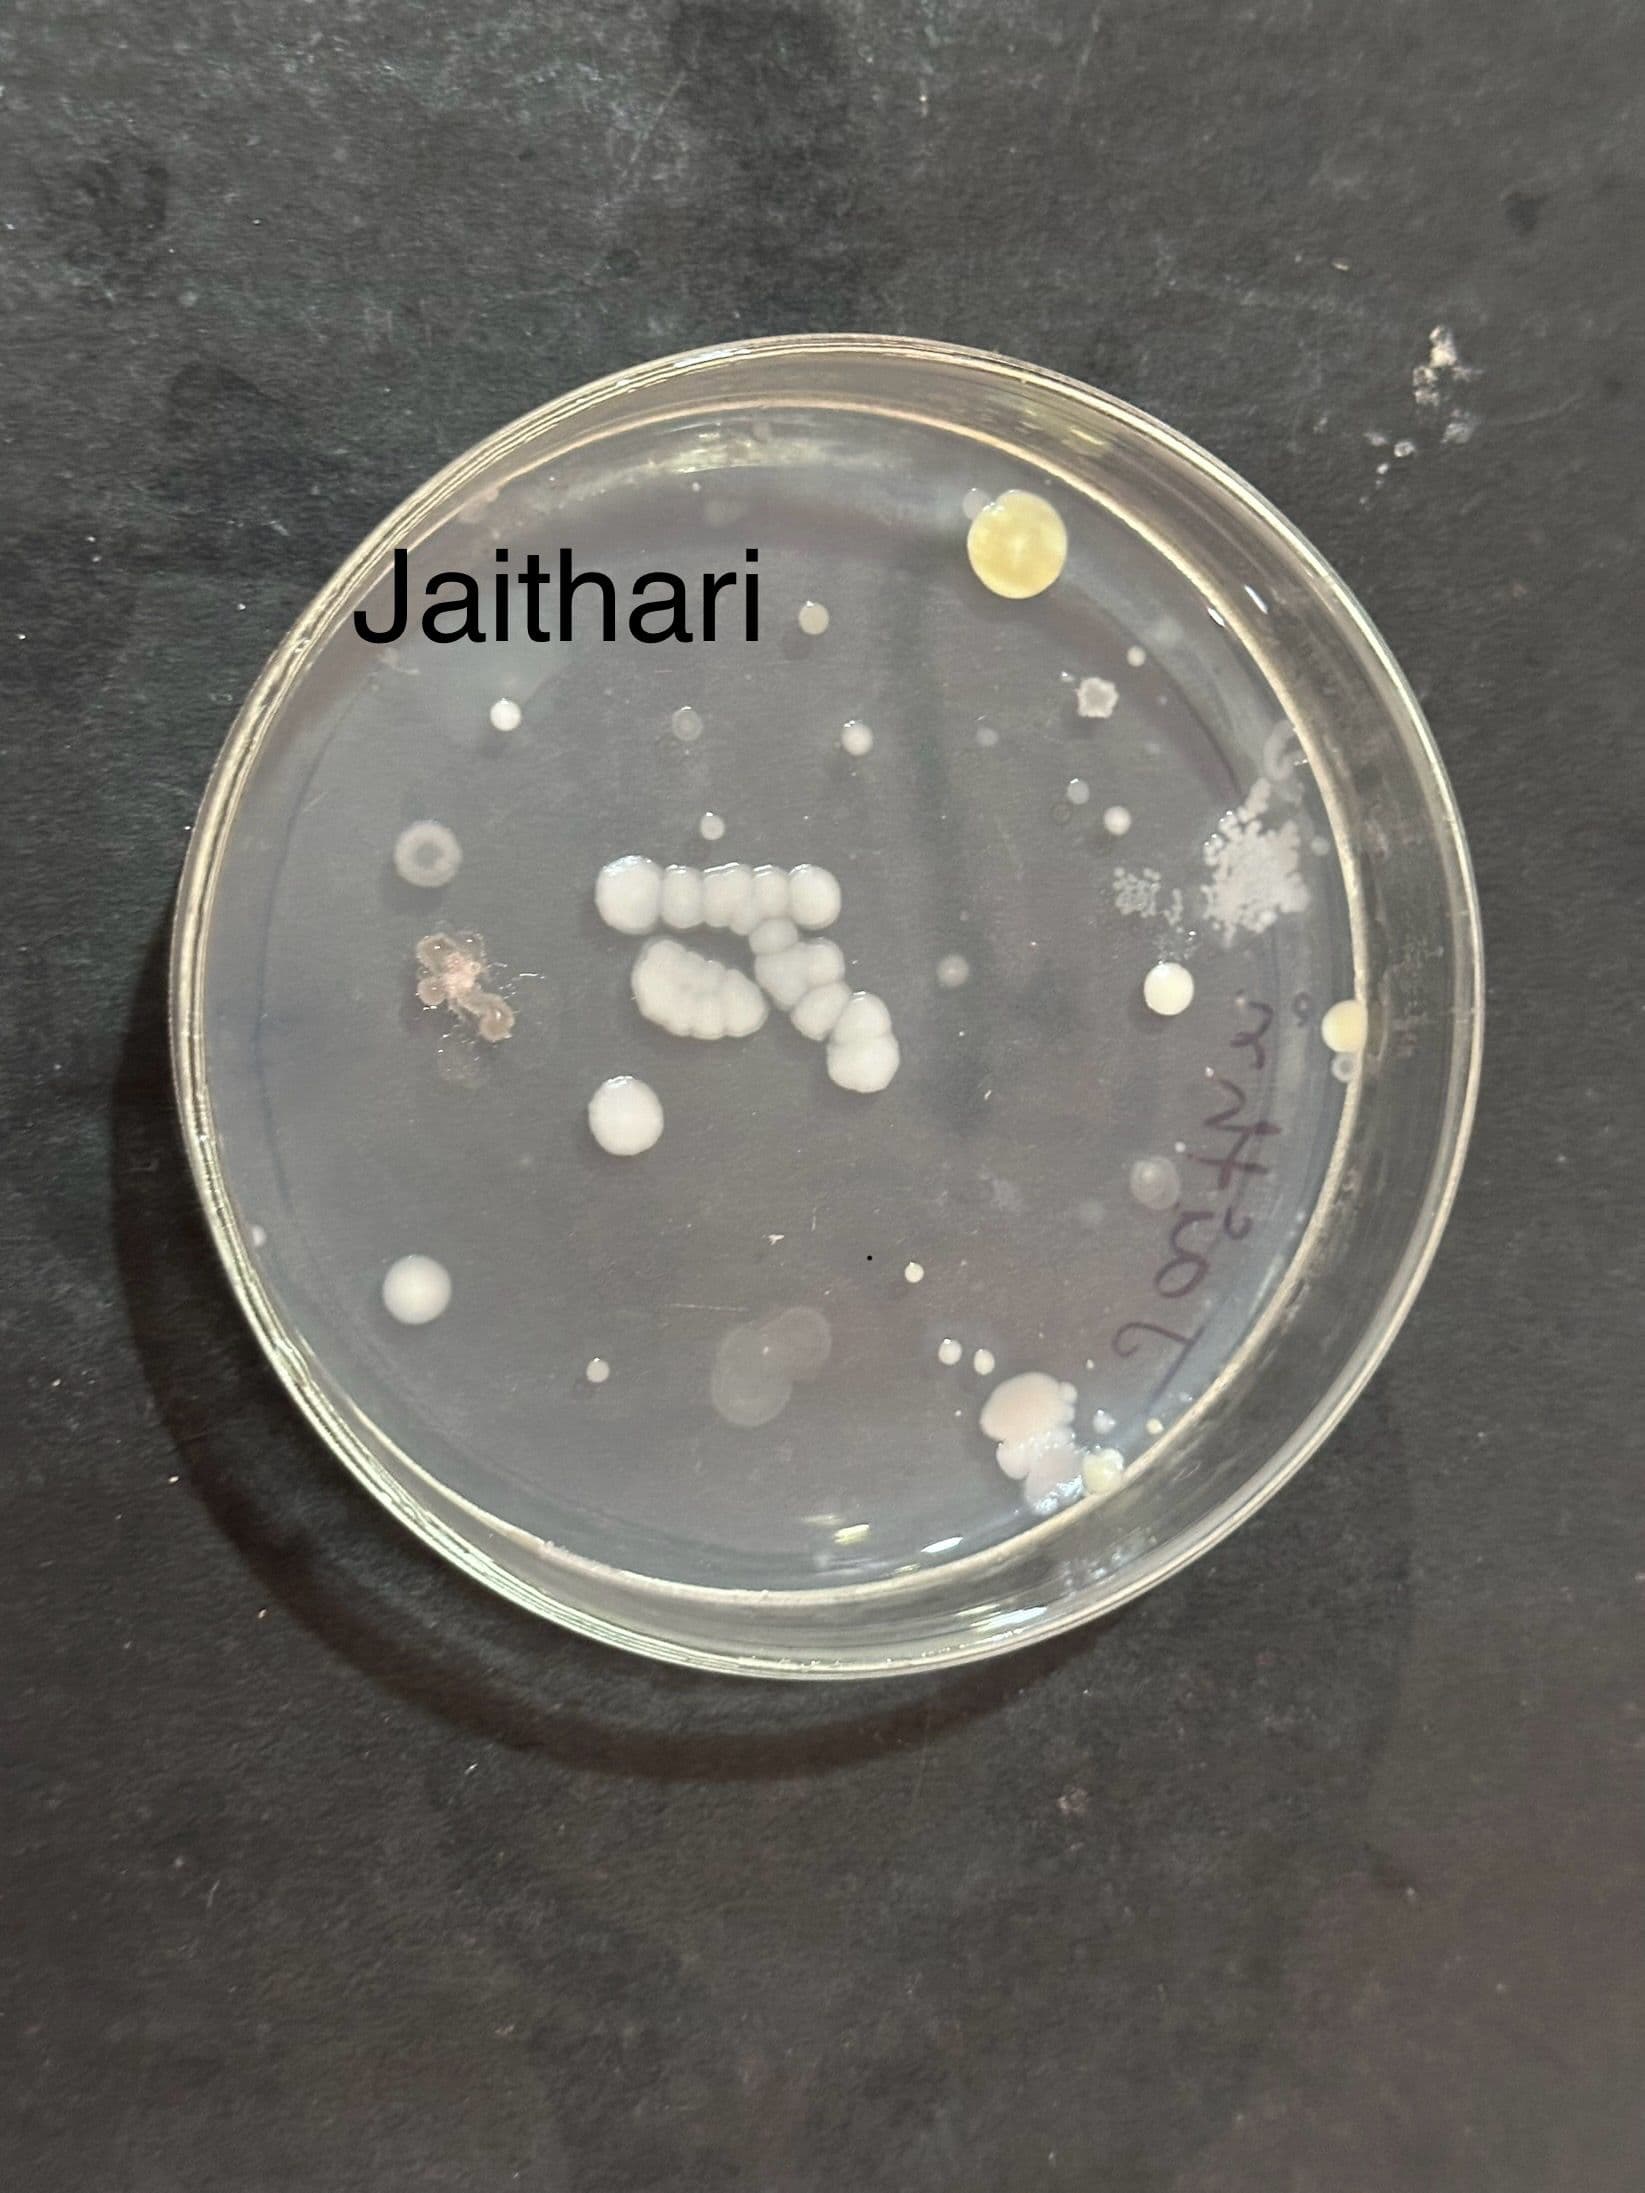
Agar plate labeled Jaithari with distinct fungal isolates
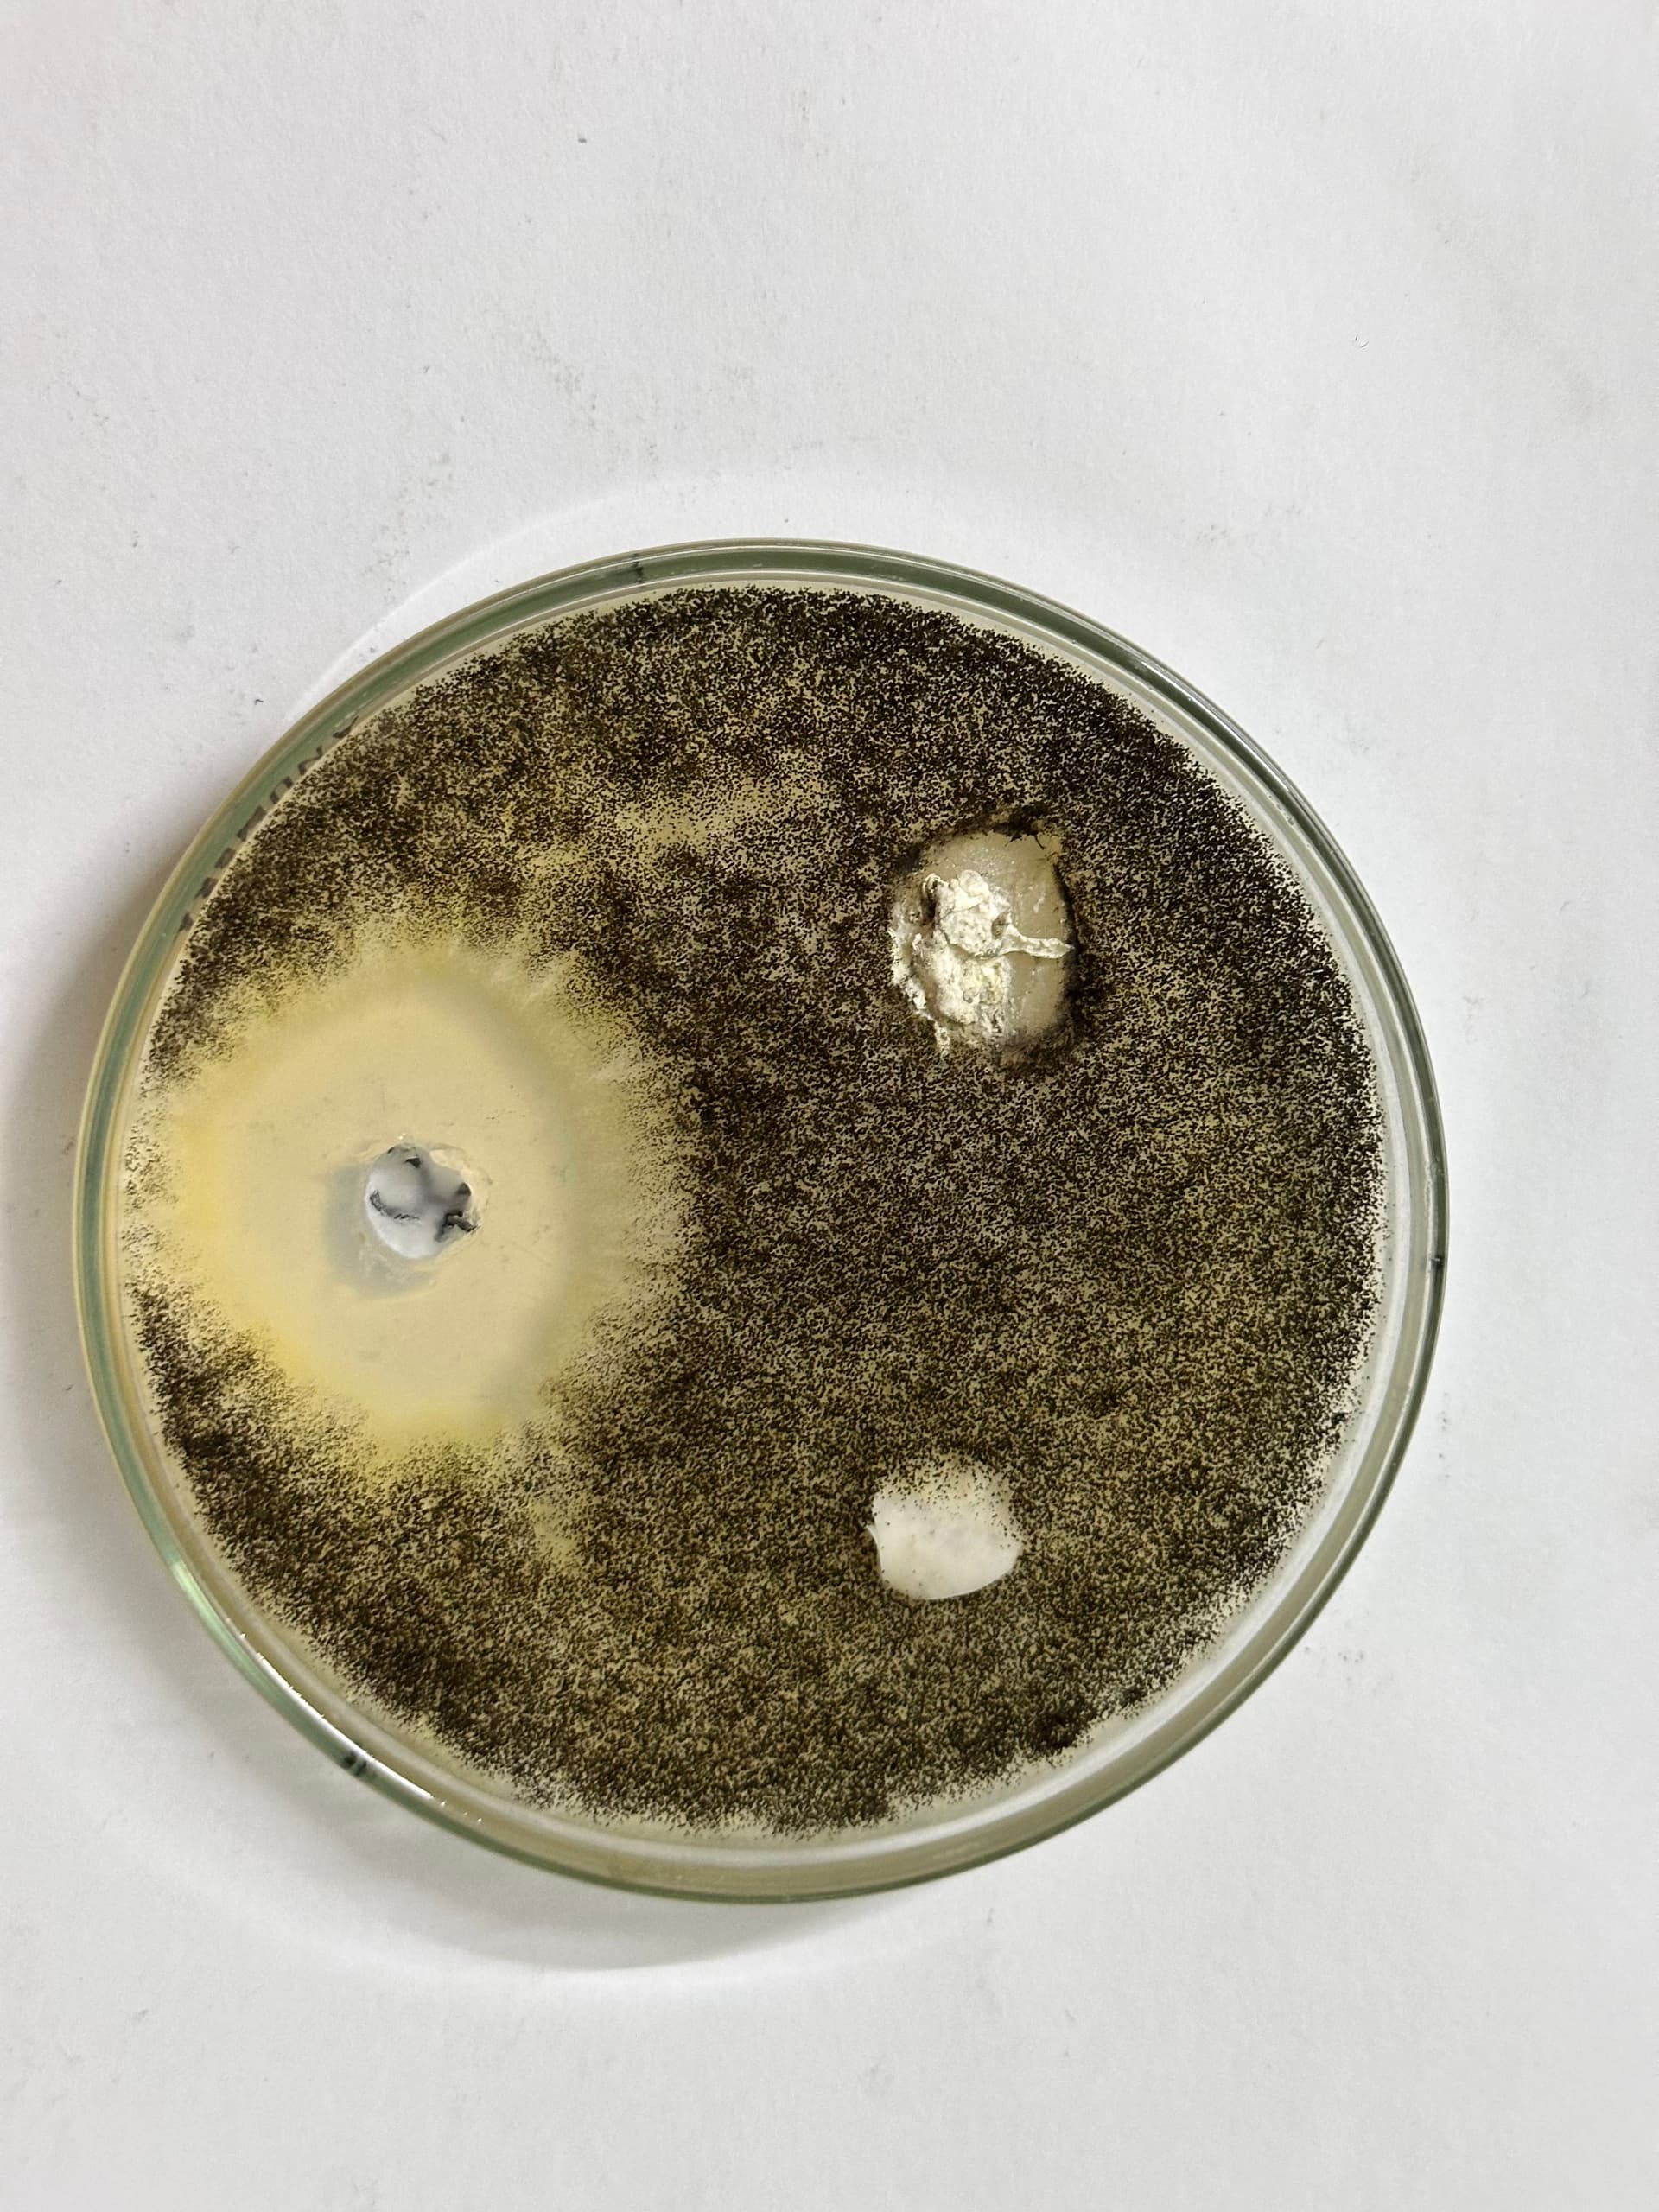
Petri dish with complex microbial growth patterns
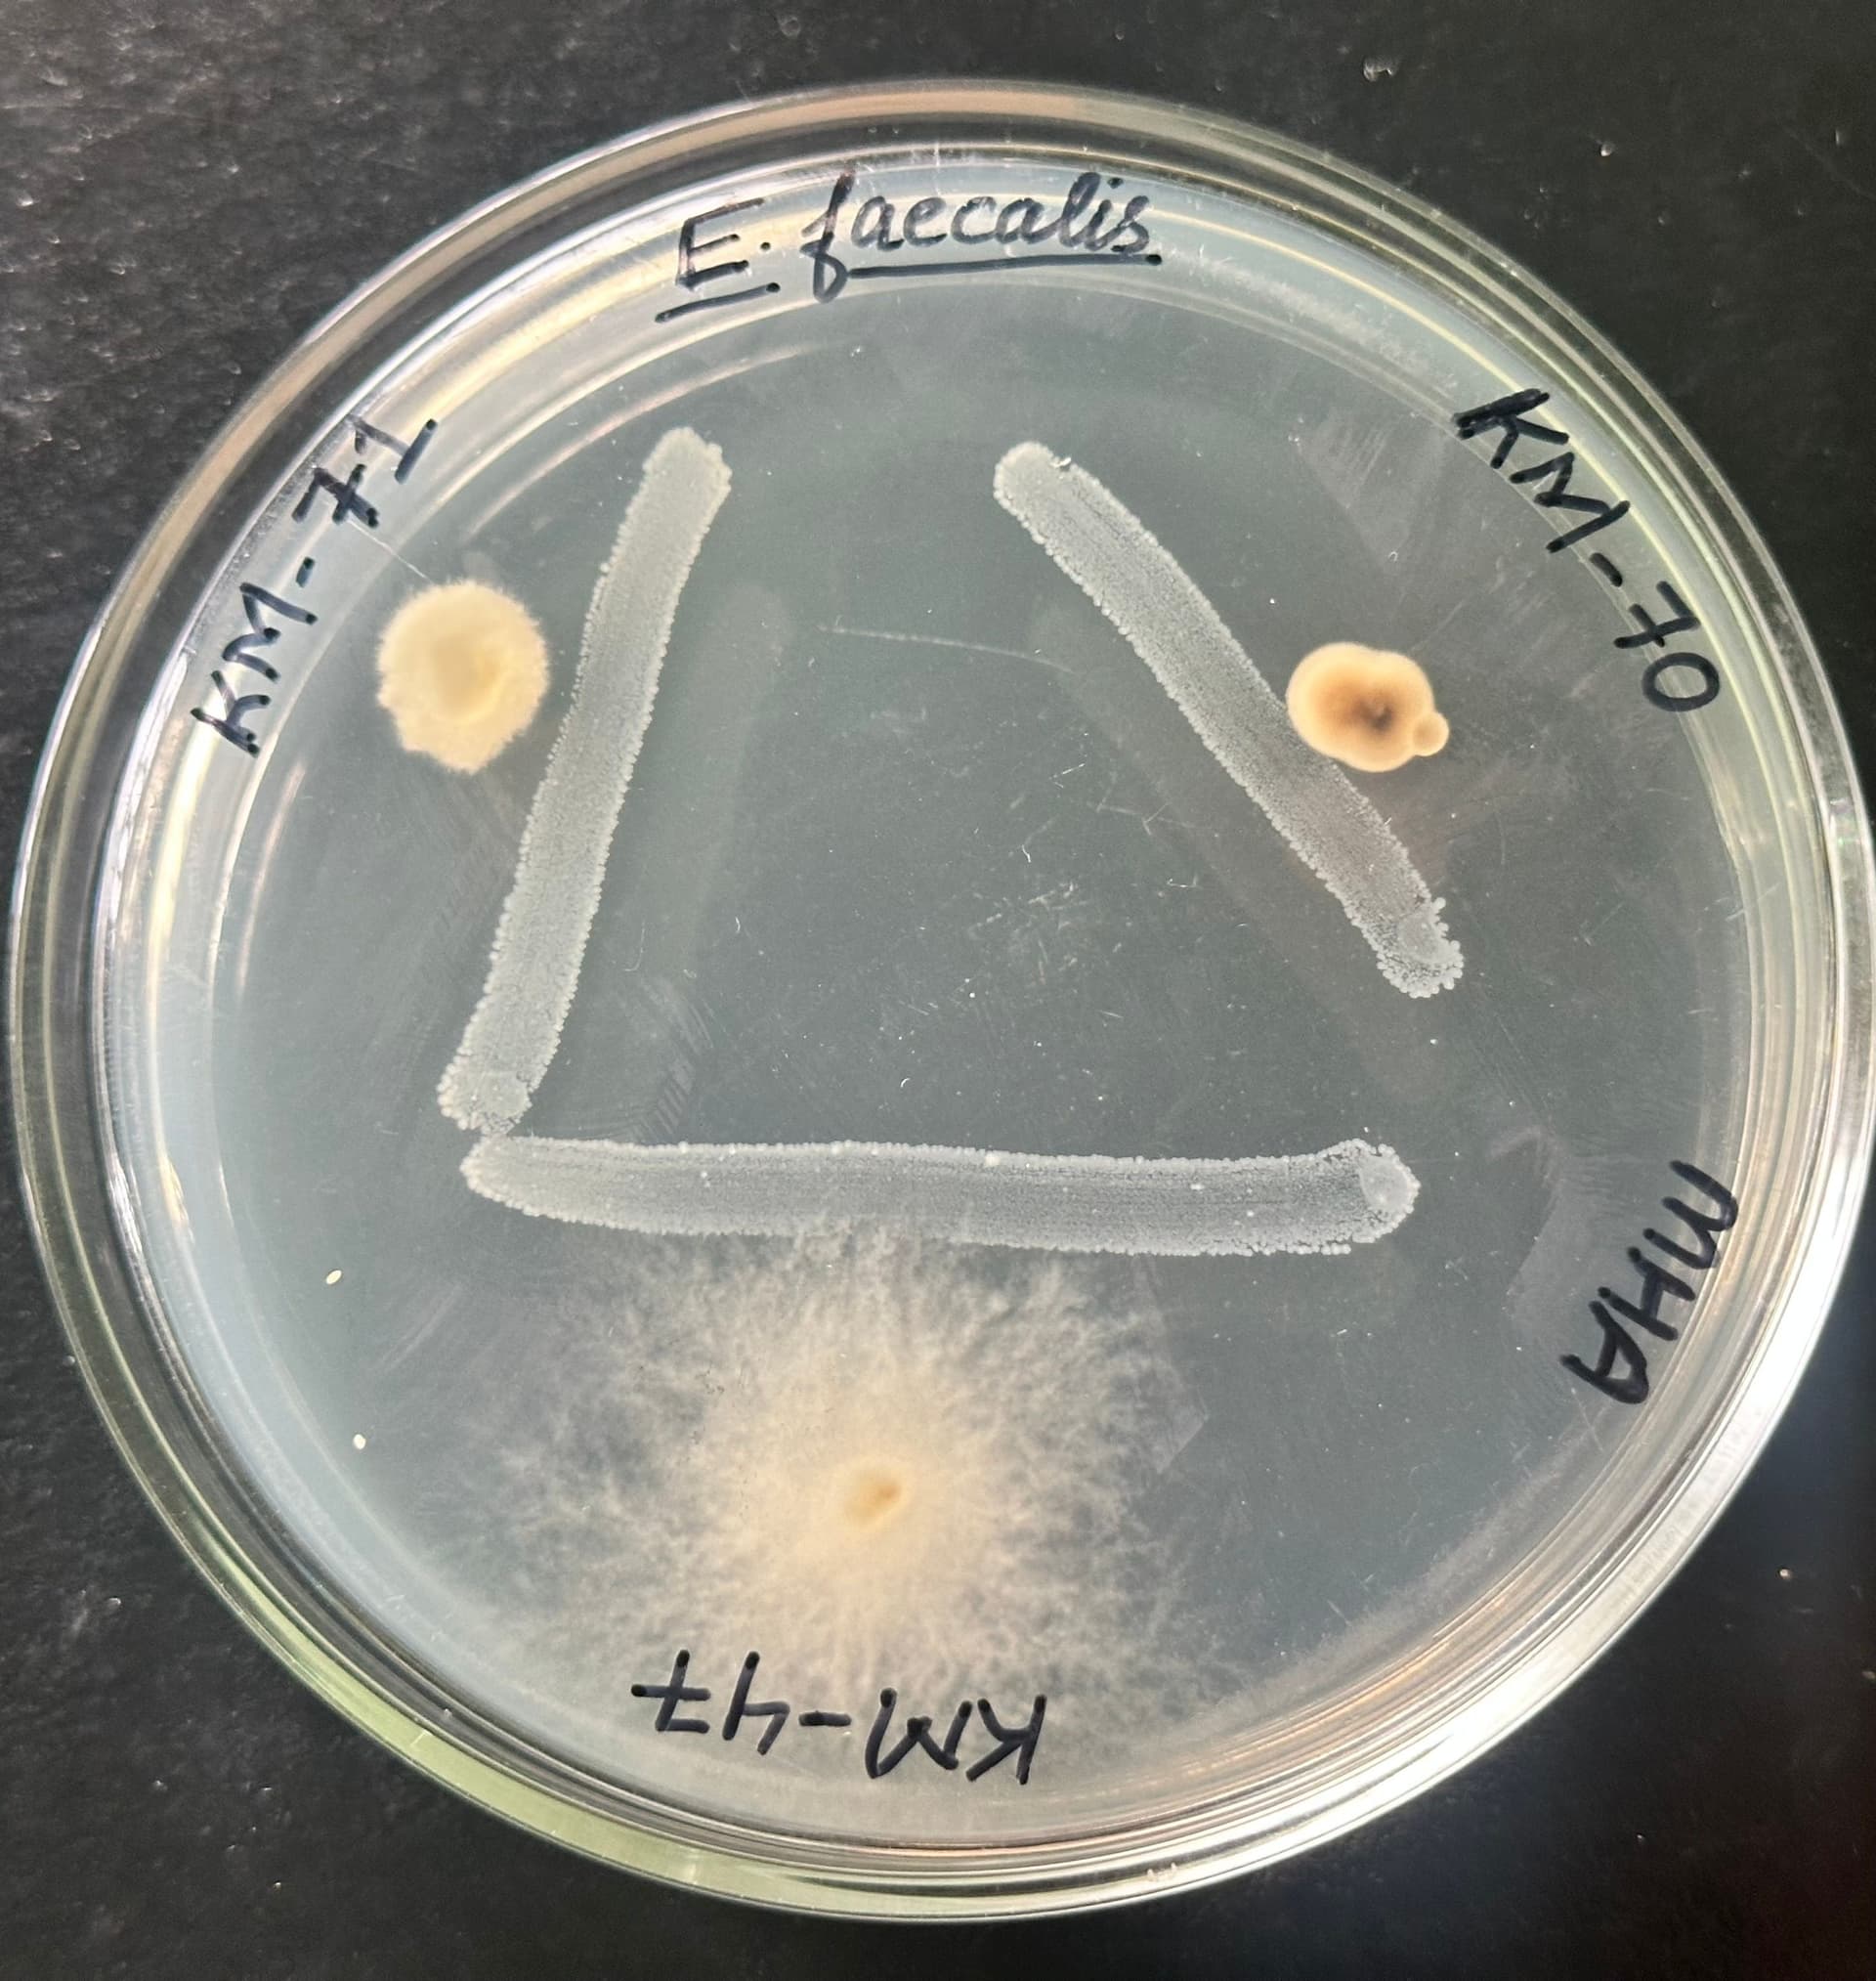
Fungal inhibition assay showing a clear zone of inhibition

Visual Overview
Laboratory & Research Gallery
Visual documentation of our biotechnology facilities, research experiments, and training programs.
Explore our laboratory environment where innovation meets excellence. This gallery highlights the daily research and academic life at our Jabalpur institution.

Laboratory Gallery
Visual documentation of our high-precision laboratory standards, biotechnology infrastructure, and collaborative research environment.